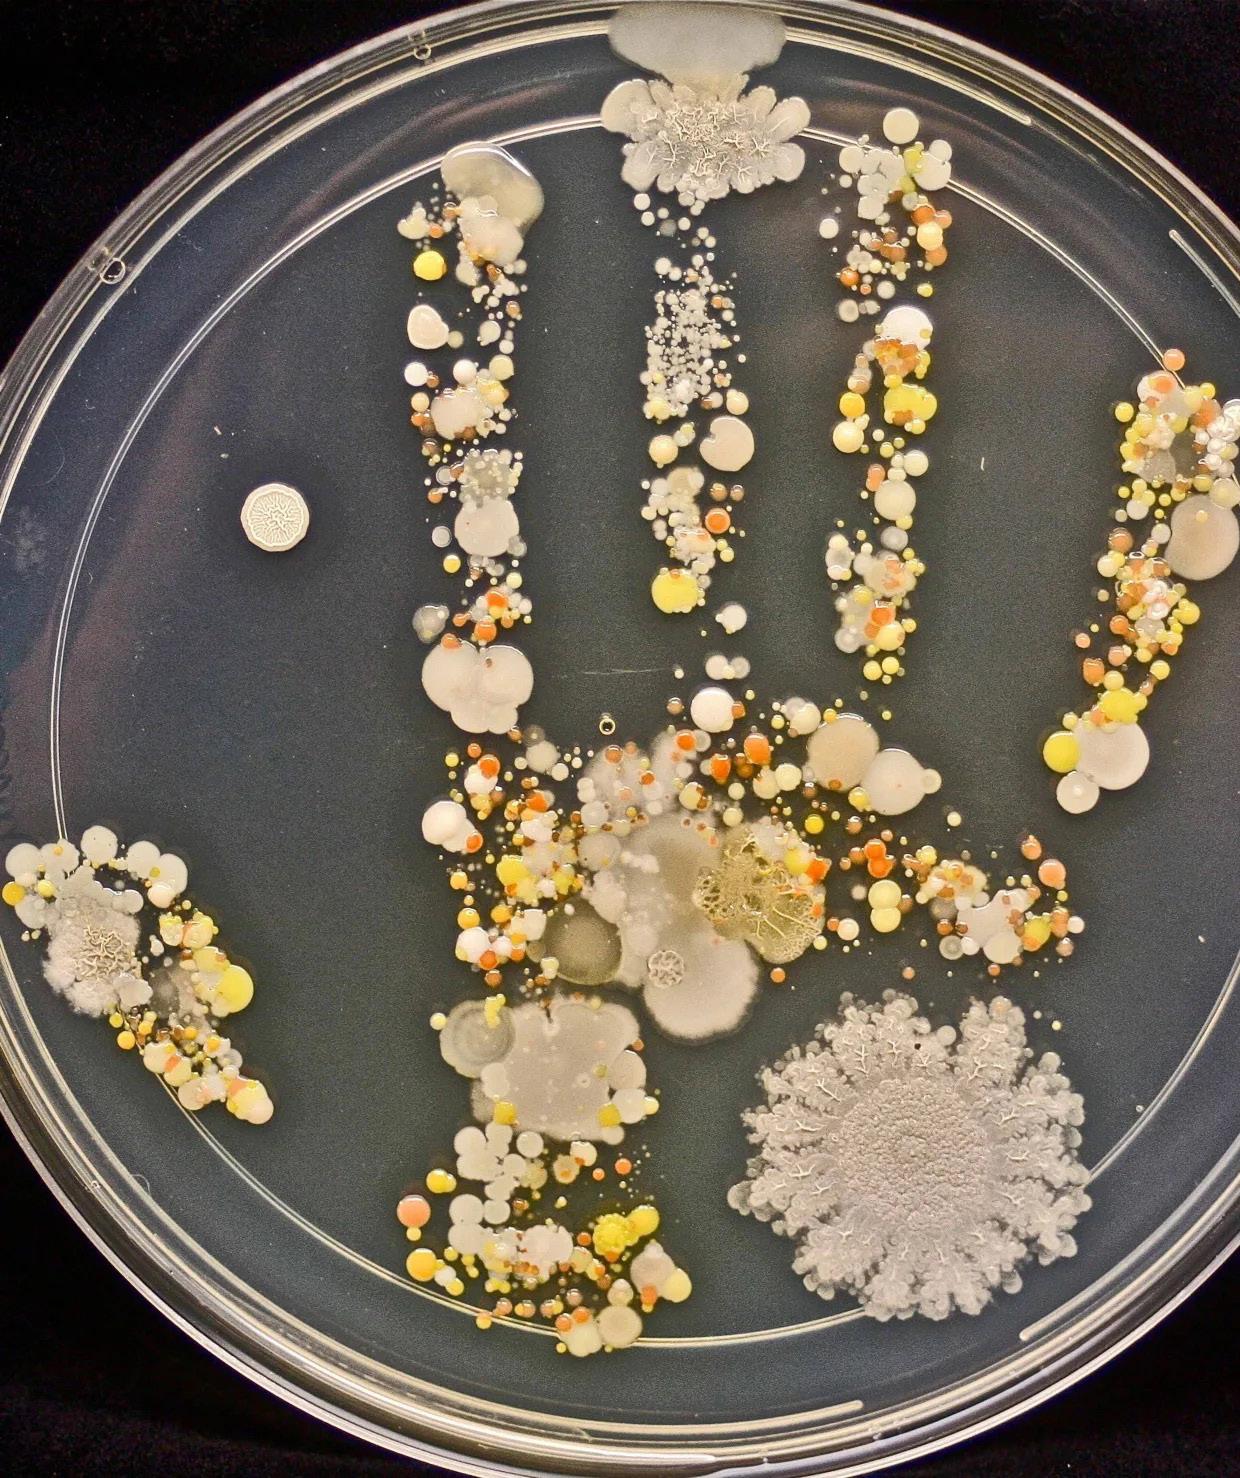

La quiebra fiscal del Gobierno de Puerto Rico y los procesos aprobados para la restructuracion de la super millonaria deuda pública han sido no sólo tortuosos, sino también extremadamente costosos y onerosos para un país y una población pobres como los nuestros. Comencemos por el entorno en el cual se han llevado a cabo.
Una ley -PROMESA-especialmente creada para Puerto Rico por el Congreso de Estados Unidos, un cuerpo de gendarmes fiscales- Junta de Control Fiscal (JCF)- también nombrado y aprobado desde Washington, con miembros y oficiales formados en la ideología y las prácticas del capitalismo neoliberal, pensamiento totalmente incongruente con las realidades de países pobres y de sus sectores trabajadores y desventajados.
La JCF llegó aquí con una hoja de ruta que ha intentado implantar al pie de la letra, causando un enorme disloque económico y social entre nuestra población.
Para empezar, no hubo la necesaria auditoria minuciosa para fijar responsabilidades entre los gobernantes y funcionarios negligentes y sus socios en el endeudamientolos conglomerados financieros de todo tipo que apostaron y contribuyeron a crear el mito de un Puerto Rico ilimitado en recursos y capacidad de pago. Además, los señores y señoras de la JCF trajeron el estilo habitual de los países ricos ante los desafíos: pagar cantidades exorbitantes de dinero para resolverlos.
La realidad sobre el terreno es otra, y los asfixiantes costos del proceso de quiebra y sus concomitantes amenazan con empobrecer aun más a los trabajadores y contribuyentes en Puerto Rico por los próximos 50 años.
Cuando en marzo del año pasado fue aprobado por el Tribunal de Quiebras de la Ley PROMESA el Plan de Ajuste de Deuda (PAD) de las Obligaciones Generales del Gobierno de Puerto Rico, esto comprometió 7 centavos de cada dólar que ingresa a las arcas públicas con el pago de esa porción de la deuda, que conllevó también unos adelantos millonarios en efectivo para aplacar el ánimo de los bonistas. Ya estamos pagando también la deuda de COFINA y de la Autoridad de Acueductos. De ahí los aumentos consecutivos en tarifas por servicios y documentos que expiden las agencias públicas, y el cargo por ajuste fiscal en la factura del agua.
Los siete años transcurridos desde la aprobación de la Ley PROMESA y la llegada de la JCF han representado una larga condena de pagos sobre pagos para las generaciones actuales y futuras en nuestro pais. En su último informe de agosto de 2022, la JCF reveló que, al 31 de julio de 2022, ya los contribuyentes de Puerto Rico habían pagado unos $1,200 millones en gastos asociados a la quiebra, a bufetes de abogados, consultores y otros profesionales utilizados en dicho proceso. En ese mismo informe, estimaron que para el 2026 ( o sea, en el décimo aniversario del comienzo del proceso de restructuracion de quiebra), la cuenta por servicios profesionales habrá ascendido a $1,600 millones. Esta cifra es casi cuatro veces mayor que los $370 millones que la Oficina de Presupuesto del Congreso de Estados Unidos estimó que costaría el proceso de quiebra de Puerto Rico en el mismo período de 2017-2026. O sea, que la misma JCF que lleva 7 años predicando e imponiendo austeridad y disciplina fiscal al pueblo de Puerto Rico, no se aplica la receta a sí misma a la hora de contratar servicios y gastar a manos llenas para facilitarse la vida y el ejercicio de sus funciones.
Mientras, en el ámbito de las iniciativas de desarrollo económico para Puerto Rico que contempla la Ley PROMESA, el informe confirma la falta de pro actividad y de gestiones exitosas de la JCF como de los gobiernos.coloniales del PNP-PPD bajo su tutela. En esa área crucial, los resultados han sido nulos
Este es el cuadro con que nuestro pueblo enfrentará ahora la restructuracion pendiente de la deuda de la AEE. Y según perfila, nada impedirá que los abonados de energía eléctrica tengan que pagar el llamado cargo híbrido y una tarifa insostenible, independientemente de la decisión de la Jueza Swain para tratar de salvar el PAD presentado al Tribunal por la JCF, y hacer avanzar la resolución del tranque con los bonistas principales que no ceden en su reclamo de pago total. Mientras tanto, nuestro pueblo seguirá asfixiado de pagos de deuda por décadas, más allá de la existencia de la JCF y de la injusta y abiertamente colonial Ley Prome.
31 DE MARZO DE 1894
LAURA MENESES DE CARPIO
Hija de Juan Rosa Meneses del Pino y Emilia del Carpio Tupayachi, nació en la ciudad de Arequipa, Perú. Esposa de Pedro Albizu Campos. Fue doctora en ciencias naturales con concentración en farmacología. Comenzó sus estudios universitarios en la Universidad de San Marcos en Lima, Perú, donde obtuvo su doctorado en Ciencias Naturales, siendo la primera mujer peruana en lograrlo. Por haber sido la estudiante femenina de mejor promedio universitario de todo el Perú, fue aceptada en la Universidad de Harvard, donde hizo un doctorado en farmacología. Laura conoce a Albizu en diciembre de 1920 y establecen una relación amorosa.
Cuando triunfa la revolución cubana, Meneses es nombrada primera secretaria de la Misión Cubana en la ONU (ella hablaba perfecto inglés) y fue miembro de la Federación de Mujeres de Cuba. También como delegada cubana de la ONU dio conferencias en Alemania del Este, Polonia y en la URSS en el Kremlin donde abogó por la independencia de Puerto Rico. Falleció el 15 de abril de 1973, en La Habana.
rriqueña, organización fundada por Juan Antonio Corretjer. Ángel conocía desde su niñez a Corretjer, quien le da la tarea de hacer círculos de estudios y organizar la Liga en su pueblo de Ciales.
En mayo de 1979 Ángel es arrestado en terrenos de prácticas navales del Navy y condenado a 6 meses de cárcel; fue enviado a la cárcel federal de Tallahassee, Florida, un presidio dominado por guardias penales miembros del KKK. El cuerpo del cialeño fue entregado mutilado y con heridas abiertas en la cabeza, a pesar de eso, el gobierno de EEUUAA dictaminó que se suicidó.
A sus cuatro años de edad partió con sus padres, Arturo Grant y Julita Chacón hacia República Dominicana “porque aún cuando mi papá tenía un bachillerato en Educación de la Universidad de Pensilvania, como era negro no conseguía un trabajo decoroso en Puerto Rico”, recordó Pedro.
Puerto Rico luego de estar encarcelado en Estados Unidos. Hubo confrontación con la policía, cientos de estudiantes arrestados, 400 expulsados, periódico estudiantil cerrado, prohibición de actividades políticas en el recinto y cuatro estudiantes independentistas encarcelados.
EUA
Suiza, país neutral durante la 2da Guerra, fue bombardeada en más de una ocasión por la aviación yanki. En Schaffhausen, una flota de 30 bombardeos mata a 40 civiles inocentes.
NACE
ÁNGEL
Del barrio Pozas de Ciales, hérore y mártir puertorriqueño de la lucha de Vieques. Fue asesinado el 11 de noviembre de 1979 mientra cumplía una condena de 6 meses en la cárcel federal de Tallahassee, Florida.
Desde muy joven Ángel Rodríguez se dedicó a la agricultura en su pueblo de Ciales. Para la década de 1960 militó en el PIP. Luego se une a la Liga Socialista Puerto-
PRESIDENTA JUNTA DIRECTIVA
Carmen Ortiz Abreu
DIRECTORA
Alida Millán Ferrer amillan@claridadpuertorico,com
DIRECTOR EN ROJO
Rafael Acevedo Rodríguez racevedo@claridadpuertorico.com
ARTE Y DIAGRAMACIÓN
Carmen Milagros Reyes
ENCARGADA DE FOTOGRAFIA
Alina Luciano
De regreso a Puerto Rico, en 1946 logró conseguir un trabajo como dependiente de la Bull Insular Line, empresa de barcos más importante de la época presidida por Miguel Such y que controlaba la mayoría de la carga de Estados Unidos a Puerto Rico. “Ahí todos los trabajadores tenían que estar unionados pero yo me negué porque yo decía que no era sindicalista. No fue hasta que el delegado de la Unión de Dependientes de Muelles (UDEM), Rafael Berríos, se me acercó y me dio una orientación, que me convenció de la necesidad de la unión”.
De ahí en adelante, se convirtió en líder sindical, independentista, miembro del MPI, PSP, del Movimiento Obrero Unido y la Unión General de Trabajadores.
(Citas tomadas de “Pedro Grant Chacón: Una vida consagrada a los trabajadores” por Perla Franco/CLARIDAD” rescatado de Red Betances.)

La protesta estudiantil se originó cuando el rector Benítez les denegó el permiso de uso del teatro para una charla con el doctor Pedro Albizu Campos, recién llegado a
ANUNCIOS Y VENTAS
Maribel Franco mfranco@claridadpuertorico.com
CIRCULACIÓN
Ricardo Santos circulacion@claridadpuertorico.com
ASISTENTE ADMINISTRACIÓN
María Montañez montanez@claridadpuertorico.com
COMITÉ EJECUTIVO
• Carmen Ortiz Abreu, PRESIDENTA
• Madeline Ramírez Rivera, SECRETARIA
• Mari Mari Narvaez
Miembros de las Fuerzas Armadas de Liberación Nacional (FALN) son arrestados en Estados Unidos y condenados a largas penas de cárcel.
Este grupo lo conformaban: Carlos Alberto Torres, Luis Rosa, Adolfo Matos, Elizam Escobar, Ricardo Jiménez, Ida Luz y Alicia Rodríguez, Dylcia Pagán, Carmen Valentín y Haydée Beltrán. En 1981 Oscar López Rivera fue detenido. Alberto Rodríguez, Edwin Cortés y Alejandrina Torres fueron arrestados en junio de 1983.
En San Juan, lanzan bomba molotov al vehículo utilizado para la distribución de Claridad.
Fuentes utilizadas: https://www.hoyenlahistoria.com/, facebook.com/dariow.ortizseda, Calendario nuestros mártires, 2020; efemerides20.com; telesur.net; historia.nationalgeographic.com; canalhistoria.es/hoyen-la-historia; Calendario 2022 Latinoamérica y El Caribe; y otros.
• Abel Baerga
• Julio Marcano
• Carlos Fraticelli
• María Rivera Figueroa
• Alida Millán Ferrer
www.claridadpuertorico.com
FB: @CLARIDAD
Youtube: periódico CLARIDAD Oficial
Twitter: @Claridadpr
Instagram: elarchivodeclaridad
Calle Borinqueña#57, Urb. Santa Rita San Juan, Puerto Rico, 00925-2732 787-777-0534
Por segunda ocasión, el Tribunal SupremLa decisión de la jueza Laura Taylor Swain, de que los bonistas de la Autoridad de Energía Eléctrica no tienen pago asegurado, si bien es un evento significativo, no supone que la Junta de Control Fiscal (JCF) vaya a retirar su plan de ajuste de deuda (PAD) presentado ante la citada jueza. La determinación de la jueza, que ve el caso de la quiebra del Gobierno de Puerto Rico y sus corporaciones públicas, fue emitida el miércoles 22 de marzo. En esta denuncia coincidieron dos conocedores del tema consultados por CLARIDAD: el licenciado Rolando Emmanuelli Jiménez y la licenciada Eva Prados Rodríguez.
El licenciado Emmanuelli Jiménez, representante legal de la UTIER (Unión de Trabajadores de la Industria Eléctrica y Riego (AEE), puntualizó que la decisión de la jueza en realidad lo que resuelve es el punto de derecho sobre la garantía de los bonos conforme al acuerdo (plan-agreement) que dio base a la emisión de los bonos. El derecho de los bonistas se limita a lo que está depositado en las cuentas especiales de la AEE, las cuales tienen entre $8 a $16 millones. Esta última cifra es lo más que podrían cobrar los bonistas.
La determinación de la juez Swain, acreditó Emmanuellli, es un evento bien significativo en la quiebra. Lo que se establece es que la JCF podría otorgarles cero pagos a los bonistas o llevar un recurso para darles solo los $16 millones. No obstante, el hecho es que el PAD preparado por la JCF ya establece que a los bonistas les van a pagar $5.4 mil millones.
El experto en la ley PROMESA indicó que no es correcto decir que la JCF quedaría en entredicho ante la jueza si quisiera presentar algo distinto y puntualizó que es la Junta la que propone el plan. La jueza Swain lo único que va a decidir es si el plan es confirmable o no es confirmable. La determinación de la jueza establece que, como cuestión de derecho, la deuda no se tiene que pagar porque la AEE está en el hueso, no tiene dinero para pagar. La decisión dice además que primero se pagan los gastos operacionales de la AEE, incluido el sistema de retiro, y, después, lo que sobre es lo que se asigna a los bonistas.
Emmanuellli considera que la JCF le está dando prioridad a los bonistas cuando ya no tiene que hacerlo y califica de absurda la situación de que a pesar de que la Junta ganó el caso que ella misma presentó, les esté ofreciendo a los bonistas una cantidad exorbitante a la cual no tienen derecho, a costa del retiro de los trabajadores y de los otros acreedores. “Si la Junta estuviera trabajando para Puerto Rico, cambiaría el plan hoy mismo y diría sabes qué acreedores, de bonos te voy a dar cero. La Junta podría hacerlo porque al no ser asegurados puede proponer lo que les va a dar, y eso es lo que no va a pasar porque la Junta juega para el equipo de los bonistas, no para el pueblo de Puerto Rico”, manifestó.
En esa línea, afirmó que solo la toma de las calles es lo que podría impugnar la negociación de la JCF. La JCF acaba de ganar un caso crucial para que Puerto Rico no tenga que pagar un cargo híbrido, por lo que recalcó que el Gobierno, tanto el Ejecutivo como la Legislatura deberían exigir a la JCF que enmiende el plan y elimine el cargo híbrido. “Como cuestión de realidad, el cargo híbrido es una imposición que no está justificada y es un regalo que le están haciendo a los bonistas; esa es la situación actual. La decisión de la jueza está muy bien fundada. Eso lo venimos diciendo desde hace años. El sistema de retiro tiene un pleito igual a este, y la jueza lo paralizó, y eso se sabe desde el comienzo”.

Para Emmanuellli,el hecho de que todavía la JCF esté proponiendo el PAD con el cargo híbrido y la eliminación del plan de pensiones significa que no ha cambiado la
versión del PAD divulgado. Se supone que la vista de confirmación del plan se ejecute en el mes de junio, pero la jueza no tiene poder para modificarlo. Los criterios para basar su determinación de si el plan es confirmable o no están en la sección 3.14 de la Ley PROMESA.
Emmanuelli Jiménez atribuyó la insistencia de la JCF en pagar a los bonistas a que parte de sus miembros juegan a las influencias entres sus grupos de interés: un quid pro quo. El ejemplo más reciente es el de la exdirectora ejecutiva, Natalie Jaresko, quien luego de renunciar a la JCF ahora trabaja con la firma Ernest Young, la cual es asesora de la propia JCF.
Por su parte, la directora ejecutiva de la Comisión Ciudadana para la Auditoría del Crédito Público (CCCP), licenciada Eva Prados Rodriguez, igual considera que, en principio, la determinación de Swain es importante en términos de lo que están exigiendo los bonistas en tanto en cuanto todavía no existe un acuerdo entre estos y la JCF.
“Sí significa un golpe a los bonistas, porque ellos pretendían que la Junta les pagara más de lo que está proponiendo. Así que en ese sentido, confirma lo que ha sido nuestra argumentación de los sectores que nos hemos opuestos al PAD de la AEE, de que sus bonos no son asegurados, que no tienen la misma categoría ni derechos que quizás vimos en los bonistas de la deuda del Gobierno central o de la Autoridad de Carreteras”.
Incluso indicó que, además de confirmar que a lo único que los bonistas tienen derecho es a lo que la AEE tiene en las cuentas para pagar, establece que tampoco tienen garantía sobre los activos. “Eso significa una importante confirmación de lo que hemos estado reclamando en cómo resolver la deuda de la autoridad. La realidad es que no tenemos con qué pagarles”.
No obstante, la licenciada Prado Rodríguez también resaltó que tampoco esta decisión significa que por defecto la JCF vaya a retirar el cargo híbrido. Por eso le preocupa que haya personas de los medios de comunicación que hablan “disparates”, reclamando que ya no van a aumentar las facturas.
“Eso no es una realidad, ni tampoco hay que defender a la Junta a capa y espada. Hay que ver el contexto, y ya ha ocurrido en el pasado. No es la primera vez que la Junta no tiene una vitoria judicial de este
tipo, y aun así negoció un PAD de la Autoridad de Carreteras con aumentos”. El PAD de la AC impuso aumento en los peajes, según el costo de vida, por los próximos 50 años y la privatización de todas las autopistas con peajes.
“No es real decir que ya resolvimos el problema del PAD. La Junta sigue con su propuesta a los bonistas con los aumentos ya discutidos. La realidad es que hay un problema con el pago de las pensiones y la Junta sigue proponiendo pagar a los bonistas”.
Prado Rodríguez recordó que la deuda de la AEE aún no ha sido auditada y que informes preauditoría señalan irregularidades en esas emisiones, como deuda que fue emitida ilegalmente por la corporación y préstamos hechos para proyectos que nunca fueron construidos.
La licenciada expuso que el planteamiento de la Comisión Ciudadana es que ante la decisión de la jueza Swain, se está
en un momento en que se puede reducir el pago de la deuda, y que de pagar algo, sea para el pago de las pensiones y que sea algo mínimo que no afecte la economía de Puerto Rico.
A juicio de la licenciada Prado Rodrí-
guez, la estructura que está proponiendo la JCF es desastrosa para la economía del país y es criminal. “Esa exigencia que se le debe hacer a la Junta lo debe exigir el Gobierno; pero no estamos escuchando a los políticos hacer esa exigencia”.
La Asociación de Maestros de Puerto Rico (AMPR) expresó preocupación por la fuga de maestros que son reclutados en Puerto Rico para trabajar en diferentes distritos escolares de Estados Unidos. El éxodo es consecuencia de las condiciones laborales que vive el magisterio público en nuestro país.
En comunicado de prensa, el presidente de la AMPR, Víctor Bonilla Sánchez, expuso que varios distritos escolares en Estados Unidos continúan utilizando a Puerto Rico como banco de talento para contratar maestros bilingües y de materias de difícil reclutamiento. “Para evitar que esto siga ocurriendo hay que continuar la lucha por un salario justo, identificar los fondos para considerar las alternativas al retiro, proveer mejores condiciones laborales y de desarrollo profesional y completar la activación de la Carrera Magisterial para que sea efectiva, apoyando la formación profesional”, aseguró Bonilla Sánchez.
Para el presidente de la AMPR y el secretario general de la Local Sindical, Ángel Javier Pérez Hernández, estas actividades de reclutamiento son otro indicador determinante para que el gobernador, el secretario del Departamento de Educación (DE), Eliezer Ramos Parés, y la Asamblea Legislativa propongan mecanismos urgentes para mejorar las condiciones de empleo del personal docente en el sistema educativo público.
“Presentamos nuevamente nuestro re-
clamo al gobernador, Pedro Pierluisi, así como a los presidentes del Senado y de la Cámara, para que respondan a nuestras propuestas y nos presenten planes de acciones concretas que detengan esta fuga de docentes. Hay que establecer una escala salarial conforme al costo de vida. Es urgente que se active la Carrera Magisterial, pero, sobre todo, es apremiante identificar los fondos para considerar las alternativas al retiro que garanticen una pensión justa para que nuestro magisterio pueda gozar de una jubilación estable y sin preocupaciones. Lamentablemente, hoy día en este país muchos maestros retirados están prácticamente en la indigencia”, añadió Bonilla Sánchez.
Por su parte, Pérez Hernández destacó que “nuestro sistema de educación pública no puede continuar perdiendo talento. Sin educación pública no hay progreso académico para la mayor parte de la niñez y la
juventud, que ve en la educación pública la herencia y pertinencia del pueblo y el mecanismo de movilidad social. Nuestros educadores son quienes sostienen esa promesa de vida para gran parte del país”.

Ante esta situación, la Asociación de Maestros de Puerto Rico con su Local Sindical hicieron un llamado al gobernador y a los líderes de la Asamblea Legislativa, mediante comunicaciones formales, para que se retomen las discusiones sobre el retiro de los maestros, se cree una justa escala salarial y se aseguren términos y condiciones de trabajo óptimos que viabilicen la retención del magisterio.
CLARIDAD tiene constancia de los esfuerzos de estos reclutamientos dado a que en múltiples ocasiones en su correo de Redacción ha recibido comunicados en los que se anuncia la visita de diversos grupos, como el Teach for America, de Connecticut.
La determinación de la jueza establece que, como cuestión de derecho, la deuda no se tiene que pagar porque la AEE está en el hueso, no tiene dinero para pagar. La decisión dice además que primero se pagan los gastos operacionales de la AEE, incluido el sistema de retiro, y, después, lo que sobre es lo que se asigna a los bonistas.
ARV es ser la agencia líder en la prestación de servicios que garanticen la competitividad de las personas con impedimentos en el mercado de empleo y su derecho a una vida más independiente”. El presupuesto de esta agencia se cubre con 20 % de fondos estatales y 80 % de fondos federales para servicios y nómina.
El Colegio de Profesionales de la Consejería en Rehabilitación (CPCR) denunció como un plan de clasificación incongruente, que demuestra desconocimiento de las profesiones reguladas por el mismo Estado y atenta contra el espíritu de la normativa que lo promueve, el nuevo Plan de Clasificación de Puestos de Carreras del Gobierno central, el cual colocó en una categoría 4 a estos profesionales.
La presidenta del CPCR, licenciada Dalila Luyando Santiago, en entrevista con este semanario indicó que el Gobierno no les ha dado ninguna explicación respecto a los criterios para esa clasificación. Expuso que el Plan no establece criterios con relación a la ubicación. Lo que se habla en general como justificación es que el propósito del plan es atemperar los sueldos al mercado laboral y, en el caso de los puestos que son de difícil retención, reconocerlos. Esto contrasta con que cuando se va al Plan, el profesional de consejería en rehabilitación de la Administración de Rehabilitación Vocacional (ARV) lo colocan en una categoría 4.
Luyando Santiago defendió que los profesionales de la Consejería de Rehabilitación Vocacional tienen el requisito de maestría, con una licencia que se tiene que revalidar con la Junta Examinadora del Consejo de Rehabilitación del Departamento de Salud. Además, tienen colegiación compulsoria y, para poder mantener la licencia, tienen que cumplir con educación continua con el propósito de mantenerse actualizados en sus áreas de competencia. Al consejero de rehabilitación de la ARV lo ubican cercano a un auxiliar fiscal o un
coordinador auxiliar en el desarrollo del niño, en ocupaciones técnicas de menor preparación y requisitos académicos.

“No se entienden cuáles son los criterios que se utilizaron para colocarlos en esa categoría, cuando ellos son el único profesional autorizado por ley para proveer servicios en la Administración de Rehabilitación Vocacional”.
El total de estos profesionales en Puerto Rico es de 521, de los cuales 210 trabajan en la ARV, con un sueldo actual de apenas $2,050. El resto está en otros escenarios laborales, como hospitales, colegios, universidades, ASMCA “Estamos hablando de que a profesionales que están en la ARV, se les ubica como consejero en una escala IV. ¿Cómo se va a atraer a un profesional de esa envergadura?”, se cuestionó la licenciada Luyando Santiago. Agregó que de no modificarse el plan, las personas con diversidad funcional, que ya están en una situación de vulnerabilidad, se verán en una situación de mayor vulnerabilidad al no tener un profesional que trabaje de acuerdo con lo que está establecido en la ley.
El Colegio trajo a la atención que la ARV es la agencia estatal designada bajo las disposiciones de la Ley Pública Federal 93-112 del 26 de septiembre de 1973, según enmendada, conocida como la “Ley de Rehabilitación” y la Ley Núm. 97 de 10 de junio de 2000, según enmendada, conocida como la “Ley de Rehabilitación Vocacional de Puerto Rico”, para administrar los fondos federales y estatales dirigidos a ofrecer servicios de Rehabilitación Vocacional a las personas con impedimentos elegibles.
“La misión es integrar a las personas con impedimentos a la fuerza laboral y a una vida más independiente. La visión de la
Luyando destacó que en comparación con la categoría asignada a los consejeros de la ARV, el consejero ocupacional del Departamento del Trabajo y Recursos Humanos (DTRH) fue clasificado en una posición 12, puesto que puede ser ocupado por un consejero de rehabilitación vocacional. Mientras al consejero ocupacional del DTRH se le asigna una escala salarial de $44,300 anuales en el nuevo plan de reclasificación, al consejero en rehabilitación de la ARV se le asigna apenas $24,600, algo que resulta contradictorio por demás cuando la ARV está bajo la sombrilla del propio Departamento del Trabajo.
Otros ejemplos de incongruencias son que al consejero en lactancia, que no necesariamente tiene que poseer un grado en medicina o ser médico asistente, sino que puede ser una persona con un certificado posbachillerato en Nutrición y Dietética o un bachillerato en Enfermería Generalista, tiene una clasificación de12, con una escala salarial de $53,600 anuales. Según el CPRV, el trabajo del consejero en lactancia consiste en asesorar, evaluar y apoyar a las participantes de lactancia materna del Programa WIC en una Agencia del Gobierno de Puerto Rico.
“Reclamamos que ese plan sea revisado. El impacto no es solo con los consejeros. Los técnicos de rehabilitación de la ARV, que tienen un bachillerato en rehabilitación, también fueron clasificados con una escala 1”.
Otras profesiones clasificadas son, por ejemplo, analista en determinación de incapacidad 2, que fue puesto en una categoría 8; analista en determinación de incapacidad 3 y 4, que fue clasificado en 9; intérprete del lenguaje de señas e interprete de sordos, en una clasificación 9.
Todas estas clasificaciones significan una escala de sueldo mayor a las de la Consejería de Rehabilitación Vocacional.
¿Qué impacto tendrá la salida de Carmen Yulín Cruz del Partido Popular Democrático (PPD)? Esta pregunta ha aparecido en algunos medios de prensa luego de que la exalcaldesa de San Juan anunciara en conferencia de prensa su desafiliación del partido por el cual intentó aspirar al cargo de gobernadora en 2020. En la primaria de ese año obtuvo el 13% de los votos, quedando en tercer lugar. En dos ocasiones previas, 2012 y 2016, fue electa alcaldesa de San Juan, posición que siempre se ha visto como el segundo cargo político más importante del país.

A pesar de ese historial a todas luces importante, mi contestación a esa pregunta sería que el impacto de la desafiliación dentro del partido que abandona en estos momentos será limitado. Esta apreciación no responde a una visión desvalorada de la exalcaldesa, sino a la realidad del PPD actual o, más bien, a lo que es ese partido desde antes de aquella primaria en la que pretendió ser aceptada como candidata a la gobernación.
A mediados de 2020, cuando se celebró la primaria, ya el PPD era un partido disminuido, bastante más débil del que gracias al apoyo de otros sectores había ganado la gobernación, la Legislatura y la alcaldía de San Juan en 2012. Su proyecto político basado en la ficción del ¨estado libre asociado¨ se había derrumbado tras las acciones unilaterales del Congreso de Estados Unidos en 2016, que hizo volar en pedazos toda la ¨autonomía¨ que el partido reclamaba. La imposición de la ley PROMESA y el grupo de sentencias del Tribunal Supremo estadounidense reafirmando la aplicación sin límites de la llamada ¨cláusula territorial¨ de su constitución, hicieron desaparecer la burbuja que los fundadores del ¨ela¨ habían creado desde 1952.
Además de quedarse desnudo ante el colonialismo, el PPD acentuó su viaje hacia la derecha aumentando su parecido con el PNP e intentando ocupar el espacio del fundamentalismo religioso. Cuando anunció sus aspiraciones a la gobernación por el PPD, dijimos en CLARIDAD que en ese partido una mujer como Carmen Yulín, que mantenía posiciones progresistas y soberanistas, no tenía posibilidad alguna de ser seleccionada como su dirigente principal, y así ocurrió.
Todos los que se habían acercado al PPD
en 2012, permitiéndole los triunfos electorales de ese año, lo habían abandonado cuando se celebró la primaria. Tras la elección de 2020 se fueron los que habían insistido en quedarse tal vez atraídos por figuras como la alcaldesa de San Juan. En el 15% de votos que obtuvo el Movimiento Victoria Ciudadana (MVC) en 2020, y hasta en el 14% que votó por el Partido Independentista (PIP), están los integrantes del sector que hasta las elecciones de 2016 todavía pensaba que el PPD tenía redención.
Desde entonces, es lógico suponer que la sangría interna que ya se manifestaba en el PPD ha continuado acentuándose. Su camino hacia la derecha y la identificación con el fundamentalismo religioso es ahora más evidente, mientras su insistencia en la existencia del ¨ela autónomo¨, después de PROMESA y las reiteraciones del Tribunal Supremo, algunos las toman con pena y otros con risa. A lo anterior se añade que el liderato que quedó a cargo del partido a partir de 2020, además de creer en esas posiciones, proyecta torpeza y debilidad. Como si lo anterior fuera poco, los casos descubiertos de corrupción han golpeado de forma abrumadora a las administraciones municipales, el área donde el PPD mantenía preeminencia.
Obviamente, una persona como la exalcaldesa de San Juan, que tras dejar el car-
go en 2021 seguía proyectándose como progresista y feminista, carecía de espacio en ese partido, por lo que su salida no deja ningún vacío. Además, el sector del PPD al que ella apelaba o que se identificaban con sus posiciones progresistas, ya había abandonado el partido cuando ella finalmente anunció su desafiliación. La mayoría de esas personas votó por el MVC en 2020 o se ha acercado a ese movimiento desde entonces. Todo indica que el anuncio de desafiliación llega un poco retrasado. Por eso decía al principio de este artículo que la noticia tendrá muy poco impacto en el PPD, porque allí queda muy poca gente capaz de identificarse con sus enfoques. Sale, además, de una colectividad tambaleante, desprovista de proyecto político, que en 2020 vio reducir su apoyo a un 30% y que desde entonces ha continuado jalda abajo. Sin embargo, el hecho de que Carmen Yulín no llegue a su nueva etapa de ex popular arrastrando una masa de seguidores porque estos se le adelantaron, no la deja sin futuro político. Sigue siendo una figura importante dentro de la política isleña, por lo que quienes trabajan en la construcción de un nuevo proyecto político-electoral que sea capaz de acabar con el bipartidismo corrupto, deben encontrar la manera de incorporarla. Ese proyecto tiene el reto permanente de sumar, nunca restar.
MIRADA AL PAÍS
Hacía algún tiempo que no iba a el Capitolio de Puerto Rico a otra cosa que no fuera participar en alguna de las múltiples protestas que allí son convocadas para manifestar indignación y exigir acción en torno a los desmanes y atropellos que enfrenta el Pueblo. Trato de proteger la paz de mi espíritu de los procesos legislativos que, con frecuencia, carecen de sentido común y nada tienen que ver con las necesidades de la gente que paga los salarios de quienes allí se sientan literalmente, pues lo hacen sin ningún propósito que lo justifique. Las pocas veces que el activismo por la defensa de los derechos humanos y la responsabilidad de hacer alguna aportación a favor de la equidad y la justicia o la necesidad de representar a alguna organización requieren que comparezca a alguna vista pública o sesión legislativa, casi me obligo a hacerlo, pues sé que saldré de allí disgustada y, casi siempre, con un desagradable sentimiento de vergüenza ajena.
Así ocurrió con la vista de confirmación de la Procuradora de las Mujeres designada, Vilmarie Rivera Sierra, el pasado 16 de marzo. El proceso estuvo a cargo de la Comisión de Nombramientos del Senado, la cual dirige José Luis Dalmau, presidente del cuerpo legislativo y, hasta el próximo mayo, del Partido Popular Democrático (PPD). Luego de caminar un largo trecho bajo el sol candente por la Ave. Constitución, debido a la distancia del estacionamiento, de esquivar las patéticas estatuas de los presidentes de Estados Unidos que han visitado el País (afortunadamente todavía no han colocado la de Donald Trump con el rollo de papel toalla en alto), me uní a las compañeras que llegaron allí con el mismo propósito. Tengo la certeza de que la mayoría de las personas en el salón de vistas favorecíamos el nombramiento.

Entonces, comenzó “la función”. Entre los primeros en llegar estuvo Thomas Rivera Schatz del Partido Nuevo Progresista (PNP) con el gesto hosco que lo caracteriza. Se arrellanó en la silla, como si estuviera viendo televisión en su casa. También hizo acto de presencia Joan Rodríguez Veve del Proyecto Dignidad (PD). Otras senadoras y senadores del PPD y del PNP también asistieron. Uno de los últimos en presentarse fue Gregorio Matías Rosado, quien hizo gala de su carácter destemplado y tono irrespetuoso en la formulación de pre-
guntas a la Procuradora. Con la presencia de María de Lourdes Santiago del Partido Independentista Puertorriqueño (PIP), de la Lcda. Ana Irma Rivera Lassén y Rafael Bernabe de Victoria Ciudadana (VC), nos sentimos dignamente representadas y respiramos un poco mejor. La Sra. Rivera Sierra hizo gala de una gran serenidad cuando leyó una ponencia muy completa en la cual destacó su procedencia familiar, formación académica y profesional, el compromiso con la defensa de los derechos de las mujeres y experiencias de trabajo en el albergue para sobrevivientes de violencia de género que dirigió, en la creación y presidencia de la Red de Albergues y como representante de las organizaciones no gubernamentales de mujeres (Ongs) en el Comité de Prevención, Apoyo, Rescate y Educación de la Violencia de Género (PARE).
De manera precisa, que denota el trabajo que ha estado haciendo desde que llegó a Oficina de la Procuradora de las Mujeres (OPM), la deponente describió lo que encontró cuando llegó a la entidad. Por su relato confirmamos lo que las organizaciones de mujeres habíamos estado denunciando desde el activismo: escasez de recursos humanos, falta de diversificación en la búsqueda de fondos para poder hacer la labor que la ley orgánica de la procuraduría (Ley de 20 de 2001) le exige, la inexistencia del Consejo Consultivo de la OPM, que la Junta de los Programas de Desvío está inoperante y no supervisa los programas probatorios para las personas convictas por la Ley 54 de Violencia Doméstica, entre
muchas otras cosas. También abordó su propuesta de plan de trabajo, que no está limitada, como no debe estarlo, al grave problema de la violencia machista, sino que incluye también las necesidades de desarrollo económico vinculado a la pobreza de las mujeres, el acceso a los servicios de salud, la escasez de viviendas, el vínculo con las ONGs, por mencionar algunas. Las preguntas de Rivera Schatz estuvieron dirigidas a algunos de los hallazgos de unas monitorías que la OPM le hizo al albergue que la designada dirigió durante 18 años. No son recientes, no tienen que ver con malversación de fondos y los señalamientos fueron corregidos. Tanto así que, hasta el presente, la casa de acogida ha continuado recibiendo la aprobación de propuestas de la Procuraduría y otras entidades, incluso del gobierno federal. Era obvia la mala intención del senador quien desde que el gobernador hizo pública la designación, se opuso de forma visceral. Documentos presentados después de la vista, como exigió Rivera Schatz y algunos otros comisionados confirmaron lo dicho por la designada. Por su parte, Rodríguez Veve recurrió a su costumbre de exigir a las personas en vistas públicas que contesten con si o no las preguntas, como si estuviera de fiscala en un tribunal de justicia. Cuando la deponente le indicó en algunas ocasiones que no podía contestar de esa manera, entonces dio por sentado que la respuesta era la esperada por ella. Buscaba establecer
Sigue la página 19

1 _____ Mike Reeve Carroll; joven norteamericano que se unió a la causa emancipadora cubana y se convirtió en general de brigada del Ejército Libertador.
4 Natural de Suecia.
8 Hermann _____; criminal nazi creador de la Gestapo y de los campos de concentración.
11 Pone atención.
14 Tiempo libre de una persona.
15 Amarrar.
16 Barco de pesca, con dos proas y una vela latina.
20 Quinta dinastía del imperio chino.
23 Henry _____; participó en unas 400 acciones combativas y resultó herido en 10 de ellas.
24 Hizo mal de ojo.
26 Forma de pronombre.
27 Gansos.
29 Ave similar al avestruz, pl.
31 Símbolo del aluminio.
32 Planta intertropical de la familia de las cingiberáceas.
33 4 de _____ de 1850; nacimiento de Reeve.
35 Brooklyn, _____ York; allí nació Reeve.
37 Volví a leer.
39 Arrojas.
40 Del verbo elongar.
42 Cuatro en números romanos.
43 Raúl _____ García; revolucionario, político y diplomático cubano.
45 Conjunción.
46 Apócope de mamá.
47 Combate de _____; Reeve acompañó a Ignacio Agramonte en el enfrentamiento en que el Mayor moriría.
53 Símbolo del argón.
54 Argumentaba.
55 Árbol de la familia de las abietáceas.
56 10 de _____ de 1873; Reeve fue nombrado General de Brigada.

57 11 de _____ de 1869; fecha en que Reeve llegó a Cuba en la expedición del vapor Perrit que desembarcó en la Bahía de Nipe, en la costa norte de provincia de Oriente.
58 Guerra de los Diez _____; Reeve participó en la gesta por la independencia de Cuba.
2 Ponen en el agua el lino, cáñamo o esparto para su maceración.
3 _____, Cienfuegos; Reeve murió allí en dura batalla. Herido, luego de salvar a su gente, se dio un tiro en la sien para no caer vivo en manos del enemigo.
4 19 de _____ del año 2005; se funda en Cuba el Contingente Internacional de Médicos Especializados en Situaciones de Desastres y Graves Epidemias «Henry Reeve».
5 Fidel _____ Ruz; constituyó el Contingente Internacional […] «Henry Reeve» que hoy en día continúa su labor de ayuda y solidaridad internacional.
6 4 de _____ de 1876; fallecimiento de Reeve en
Yaguaramas en lucha por la libertad de Cuba.
7 Henry Reeve _____; aprendió el español auxiliándose de un ejemplar incompleto de «Don Quijote de la Mancha» confiscado en un asalto. Llegó a expresarse como un verdadero cubano.

9 Lengua provenzal.
10 Satélite natural de Júpiter.
12 Interjección.
13 Símbolo del tantalio.
17 En la mitología griega, centauro, hijo de Ixión y Néfele.
18 Nombre de la letra g.
19 Capa vascular del ojo situada debajo de la esclerótica.
21 Carta de la baraja.
22 Máximo _____; nombró a Reeve jefe de la caballería de la primera división el 27 de julio de 1873.
24 Establecimiento de cuido para ancianos.
25 Onomatopeya de la risa.
28 _____ da Iria; zona en la ciudad de Fátima, destino turístico religioso en Portugal.
30 Montaña zaragozana en la Depresión del Ebro.
32 Todavía.
34 Hilo de hebras dobladas.
35 Comunidad foral en España cuyo nombre en euskera es Nafarroa.
36 Asfixien.
38 _____ Agramonte; le dio a Reeve el apodo de «El Inglesito». Reeve dio a Agramonte el apodo de «El Mayor» con el cual hoy se le honra. El Mayor falleció en la batalla de Jimaguayú.
39 Capital de Perú.
41 Gas que constituye la atmósfera terrestre.
43 Dios egipcio.
44 Símbolo del oro.
47 Sistema japonés de lucha.
48 Tres en números romanos.
49 Aféresis de hamaca.
50 Amanecer.
51 Umaru Musa _____’Adua (1951-2010); fue presidente de Nigeria.
52 Producto nitrogenado que se encuentra en la orina o sudor.
De un tiempo a esta parte (¿años? ¿décadas? ¿vida?) peco del mal hábito de trabajar demasiado. No me refiero al trabajo como una virtud, el antónimo de la pereza o la acedia, aunque el producto del trabajo a veces tenga algo de eso. Tampoco se trata de personalidad: no soy trabajadora en el sentido amplio de la palabra. Admiro mucho a esa gente que cuando se aburre, se pone a barrer, pero yo soy de las que juega al escondite con la escoba. ¿Dónde la dejé, aquella vez, la última vez que la usé, dónde?
Pero con el trabajo (y al decir “trabajo” me refiero al oficio) me pasa lo contrario: no sé parar. Salgo de la cama y ya estoy pensando en el trabajo, termina la jornada laboral y me siento confundida y errante. Es sábado y abro la computadora “un ratito” sólo para descubrirme allí todavía, a oscuras, sentada y con el pie medio dormido cuatro o cinco horas más tarde.
No puedo detenerme, no sé parar.
Esto me supera, es más fuerte que yo, domina mis acciones y mi voluntad. Como lo que le pasa a un zombi, creo, excepto que no voy por ahí contagiando a nadie. ¿O tal vez sí? Pienso en el correo electrónico que le envié a mi asistente un sábado y me pregunto si los correos laborales sabatinos no serán algo así como un mordisco zombi. Pero no, quita, quita, qué va. Los zombis se distinguen por ser bobos y lentos, ¿no? ¿Y no soy yo acaso una tipa lista y eficiente, al menos en esa esfera limitada del empleo asalariado de cuello blanco y alta educación?
Hace tres o cuatro semanas, con algún esfuerzo, hice una pausa y decidí no trabajar sino ver tele, para no tener que pensar en que no estaba trabajando. ¿Qué ver, sin embargo? Buscaba algo que me agarrara, y mi esposo me recomendó la serie The Last of Us. Basada en un juego de video terrible y bellísimo del mismo nombre, protagonizada por dos actores (Pedro Pascal y Bella Ramsey) que me encantan, de trama compleja, ánimo y fotografía oscuros, melodía simple de cuerda y percusión, todos sus elementos pensados y preparados con esmero (el verdadero antónimo del pecado “pereza” o acedia es, por cierto, la virtud que se le opone, que es la diligencia, así que nada que ver con mi compulsión al trabajo y todo que ver con eso que tiene la serie, esmero), en fin, perfecta para mí. Excepto, advirtió mi esposo, por un detalle: tiene zombis.
Él sabe que no me gustan. Los zombis, digo. Pero yo ya estaba enganchada y además, añadió, son zombis nuevos. No es un virus ni magia, es un HONGO.
Ah, bueno, si los zombis lo que tienen es un hongo, eso es otra criatura, no me dará miedo, muy original, esto del hongo, disfrutaré el horror, que cuando es de calidad (y sin zombis) suele calmarme.
Esperé por un fin de semana largo, busqué un plato de queso, chocolatitos, vino, frazada, mis dos perros, y me puse a ver The Last of Us.
Y sí, era un hongo. Y vaya qué hongo, señoras. La especie existe en la vida real, aunque claro, no como esta variedad ficticia de la tele, que infecta humanos. En la vida real, los “zombis” son hormigas y otros insectos. El hongo las contagia a través de esporas, se les mete en el cuerpo, se multiplica y zas, la hormiga o el insecto que sea se comporta como una posesa y hace cosas como ubicarse en el lugar preciso para optimizar la salud del hongo y para contaminar a sus hermanas hormigas con una lluvia de esporas al morir y reventar.
Pues nada, con los humanos de la serie ocurría algo parecido, excepto que la transmisión no era con esporas sino con unos colgalejos, llamémosles zarcillos, que los contaminados atacantes usaban para transmitirle el hongo a sus atacados por contaminar. Tan bonita, por cierto, la palabra zarcillo, y yo usándola para describir algo más bien ¿feo, no, o repugnante?
No sé qué decir de adjetivos como “fealdad” o “repugnancia” en el contexto de The Last of Us. Y es que uno de los aspectos más inquietantes de la serie es, justamente, su estética. Te sorprendes a cada rato mirando, fijamente, arrobada, los colores y texturas que este novel enemigo crea-zombis, produce. No sabes si es feo o lindo lo que ves en la pantalla, pero es indudablemente un fenómeno estético, e igual pausas la acción para verlo de cerca, de lejos, con y sin espejuelos, a sabiendas de que estás alimentando la pesadilla que viene.
Todo esto que he dicho es parte de la premisa, y si digo más puedo arruinarle la serie a algún otro ingenuo que esté preparándose para verla, buscando alegremente vino, frazada y perro. Sí puedo decir que la foto que… ¿adorna? esta columna no tiene que ver con la serie pero sí con hongos, fealdad y belleza: es una fotografía del 2015, y se trata de una placa de Petri donde una bióloga californiana, Tasha Sturm, cultivó por algunos días la huella de la mano de su pequeño hijo, que venía de jugar en el patio, para ver cuántos hongos (y otros microbios) florecían. Esa imagen es un poco como esas ilustraciones en donde vemos una mujer vieja o una joven, según el ángulo o el día. Me hace pensar “belleza”, me hace pensar “fealdad”, me hace pensar que el mejor horror contiene ambas cosas, y nos obliga a buscar otras palabras.
Puedo decir también que vi todos los episodios en tres sentadas. Puedo afirmar que, como suele ser el caso con este género, los zombis de The Last of Us son parte de, pero no protagonistas de, la cosa: la verdadera trama reside en los personajes humanos, en sus relaciones y emociones, en su historia y su peregrinar. Puedo añadir que, muy a mi pesar, estos zombis serán muy interesantes y complejos y tendrán su hongo y todo, pero siguen siendo zombis y siguen sin gustarme, así que de entrada supe que tendría muchas (y muy coloridas) pesadillas.
Puedo contarles que a los zombis, en esta serie o cualquier otra más o menos reciente, no los define la inteligencia o la lentitud, sino el parasitaje, el que sea, que los supera, domina sus acciones y les arranca la voluntad.Y confesar que prendí la tele “un ratito” tres días seguidos sólo para descubrirme contaminada, zombificada y sin voluntad, cada día allí todavía, a oscuras, embelesada, sentada con el pie medio dormido, porque con esto de alimentar mi curiosidad y mis pesadillas, aparentemente, tampoco sé parar.
RAFAEL ACEVEDO EN ROJO
Nuestra isla -y sus habitantes- ha sido representada de muchas formas. Si pensamos en los años desde la firma de la ley PROMESA a los meses de encierro en la pandemia debemos concluir que solo la lucidez del sueño, la sustancia de lo imaginario, el claroscuro -paradójicamente- nos confirman que no somos una ficción. Que estamos aquí. O quizás, que somos esta formidable ficción viva.
Asistir al proceso e instalación de la exhibición de ESTA ISLA NO ES FICCIÓN de Tari Beroszi, es presenciar el modo en el que la artista, con mirada prospectiva, intenta comprender el presente y anticipa un posible futuro. Está claro que el futuro no es un lugar predefinido e inevitable, sino un espacio de posibilidades. Beroszi crea diferentes escenarios a partir de datos, investigación, observación del presente y creatividad. La artista nos dice:
Antes de comenzar a tomar las fotos para mis proyectos, escribo una declaración de artista. Imagino, escribo, leo, escribo, imagino. Este proceso se repite hasta que llega el momento de la verdad: el shooting -fotográfico, por supuesto-. Para Esta isla no es ficción, escribí durante meses. En plena pandemia, sin tener a donde ir, hice varias versiones del texto.
Durante el encierro -ese claroscuro en el que nada sabíamos de los alcances del virus- la fotógrafa se apropio de su tiempo y de su espacio para imaginar, anticipar, visualizar. Beroszi conceptualiza e inicia sus proyectos a través de un puntilloso diagrama de ideas. Es posible seguir una serie de textos sobre el arte -sobre el trabajo propio- que culmina en un trabajo como el que hoy reseñamos. Escribe:

Conceptualicé dos proyectos de exhibición durante el 2020 y 2021, en el confinamiento por la pandemia. Este es uno de ellos. Tenía el tiempo de escribir, leer e investigar todos los días. Hacía bocetos
de las imágenes que quería fotografiar. También compraba materiales en internet: papel celofán de colores, guantes, pantimedias, leotardos, sobres, letras adhesivas. Las ferreterías fueron otro lugar donde iba encontrando objetos que, al llegar allí no sabía que quería, pero al verlos lo supe. La pandemia me dio el tiempo y espacio de introspección para desarrollar la exposición que abrirá en varios días. Fueron años de temor, frustración y pérdida para muchas personas. Yo, no paraba de imaginar las escenas que, cuando finalmente pudiera acercarme a otros cuerpos, retrataría.
1. Durante los primeros días de la pandemia, se me ocurrió leer clásicos. Me interesé por la teoría de los colores de Johann Wolfgang von Goethe. La leí junto a una ventana al fondo de la casa, donde el sol era más fuerte, pensando en que así me libraría del contagio. Supe que la teoría de Goethe, quizás polemizando con Newton,
se basa en la observación y la experiencia sub-
jetiva, en lugar de en la física y la óptica. Goethe argumentaba que el color no es una propiedad de la luz, sino que es una experiencia subjetiva que surge de la interacción entre la luz y el ojo humano. He de suponer que la teoría de los colores hoy, es una rama de la física. O sé si escuchan mi tono irónico.
Lo que sí tengo claro -ya al final de la pandemia y escuchando a Tari hablar de su trabajo- es que los colores tienen una capacidad intrínseca para evocar emociones y sentimientos. Mientras trabajaba en la secuencia en la que se presentarían las fotos de ESTA ISLA NO ES FICCION disertaba sobre cómo los colores pueden afectar la percepción de la temperatura, la luminosidad, el espacio y la forma. También sobre los efectos fisiológicos como el ritmo cardíaco y la respiración. Entonces, ¿la fotógrafa tiene su propia teoría de los colores que le permite en una serie de fotos evocar lo hermoso y lo siniestro? Sin duda, hay algo sublime en la muestra. El rojo, el verde, el luminoso dorado nos guían hacia una experiencia subjetiva que une esas sensaciones aparentemente contradictoria -la contemplación de lo hermoso y lo siniestro, lo claro, lo oscuro-. Lo complicado el presente se nos presenta en un relato visual sin fisuras. Dice Beroszi:
Enfrentamos un presente complicado. Quizás coincidencia o ironía del destino, un virus pandémico en forma de corona y una ley llamada PROMESA - que no auguran honores ni bien alguno -
nos alejan del futuro que alguna vez imaginamos. La angustia que impone aislar los cuerpos entre sí, en un país aislado por su geografía y sin poder político, impide el sosiego. En una isla que cada día nos es más ajena, dejo la huella de mi existencia. Mis imágenes dicen que no somos ficción. Estamos aquí. 2
Cuerpo aislado, difuminado, con los consabidos guantes -pero estos como para cantar en una ópera clásica-, la herida en el pie. El rojo. El verde. El dorado. La tensión entre el cuerpo y el entorno o el impacto del encierro están aquí pero el ojo de Beroszi -y la presencia de elementos que facilitan la deriva de la visión- permiten explorar dimensiones emocionales y simbólicas del cuerpo.
La belleza de las fotografías no escapa a la exploración de la vulnerabilidad y a la capacidad de resistencia del cuerpo -¿acaso la belleza en su enorme espectro de posibilidades no es un modo de resistencia?-. Isla/cuerpo, espejeado en las fotografías, y allí en el centro de la exposición -como el punto cero- un espejo. Pienso en una política del cuerpo. En el arte como un mecanismo que pone a la vista -con una escritura de luz- un modo de administrar el cuerpo. Si bien se trata de una respuesta a la pandemia -y al virus colonial de PROMESA- puede extrapolarse a una puesta en secuencia de poemas visuales de los que podemos intuir reflexiones sobre el cuerpo humano como construcción social y transformados y moldeados por la acción política. Lo digo porque no ebemos olvidar cómo se administró el modo en el que nos movíamos, el modo en el que debíamos equiparnos para respirar en público. Todavía.
Para mí, que estas 30 fotografías nos permitan reflexionar sobre la forma en la que se experimenta y se comprende la propia corporalidad ante los embates de lo exterior me parece importante. Necesario. Que esa corporalidad la experimentemos a

partir de las coordenadas en las que se encuentra la territorialidad que construimos e imaginamos y cómo se le administra y niegan los recursos, como se le conmina al desarraigo, también es altamente pertinente.
Tari Beroszi, es una viajera incansable. Su formación académica lo confirma. En el directorio de artistas del Museo de Arte se destaca que terminó su Maestría en Fotografía en Spéos Paris École de Photogtaphie donde fue alumna de Georges Fèvre, impresor personal del renombrado fotógrafo Henri Cartier-Bresson. Ese interés por estudiar allí surgió de su primer viaje estudiantil. He seguido su trabajo desde que realizaba su Maestría en Bellas Artes con concentración en Fotografía del Savannah College of Art & Design en Atlanta. . Poco después de terminar su maestría gana la Beca Lexus para Artistas en el 2013. También conozco de sus viajes a la india donde realizó cursos de meditación.
Hace apenas tres años recibió el Pollock-Krasner Foundation Grant. Ha sido conferenciante invitada en la Universidad de Salamanca, en la escuela de arte y diseño LCI Monterrey en México, en L’Annexe en París y en Parsons School of Design en la ciudad de Nueva York. Su trabajo ha sido exhibido en Brasil, Hong Kong, Francia, España, Estados Unidos y Puerto Rico. A mí me gustaría decir que su modo de resistir los límites que imponen las políticas del cuerpo y las reclusiones es formidable. En medio de la pandemia viajó a Egipto y a Perú. La isla es un lugar desde el que se planifican los vuelos. Los imaginarios y los reales. Aquí estamos.
La exposición de fotografías de Tari Beroszi se encuentra en La Casa de los Contrafuertes en el Viejo San Juan. Es un hermoso espacio en el que los artistas Ana Rosa Rivera y Charles Juhasz fomentan las artes, la literatura, los intercambios y creaciones a través de prácticas colaborativas. Hay magia en ese lugar porque hay trabajo y creatividad.




Existen poetas que una vez te acercas a su obra, aunque sea leyendo por primera vez uno de sus poemas, te capturan para siempre. Son bastantes los poetas y poetisas de diferentes épocas históricas que han causado ese efecto en mí. Hoy quiero comentar de uno de ellos, Miguel Hernández, de quien tuve oportunidad de conocer algunos de sus poemas a principios de la década de 1970, siendo ya estudiante universitario. Del conjunto de su vida y obra en versos o prosa muy poco había leído. En esa etapa, mi interés académico-profesional era el estudio de la historia y la pedagogía. Mi acercamiento a la literatura y las artes, al igual que otros campos del saber, resultaban ser algo así como complementarios al estudio de la historia, pero más vinculado a ciertas contradicciones subyacentes en mi modo de pensar que, siendo asiduo lector y defensor de la teoría sociológica marxista y el materialismo histórico, cierta noción del existencialismo a partir de varias lecturas que hiciera de Kiekergarard, asignadas por el profesor Manfred Kerkhoff, para un curso de filosofía en el que estaba matriculado, con cuyas nociones acerca de la existencia del ser, sus paradigmas éticos, la vida y el ser humano, me identificaba y reafirmaban mi forma de ser y pensar.
Interpretando esa aparente contradicción entre considerarse marxista y, en la intimidad del ser, pensar y escribir desde la propia reivindicación de la utopía poética, no es otra cosa que manifestación de la complejidad y existencia del ser humano, porque lo otro sería ser simple autómata de un conjunto de ideas o dogmas a partir del cual el acto de creación científica, estética o artística se cosificaría. Por eso, lo mismo podía redactar un boletín o artículo para para su distribución a estudiantes universitarios, que escribir un poema desde la vertiente de la poesía social y de compromiso o en la tradición de la exaltación del amor, que solo mostraba tímidamente a amigos y amigas que compartían mi interés por la poesía (Erick Landrón, Vilma Dones, Jazmina, Linda Ramos, Raquel y Elizabeth Brailoswky y a mis hijos). Y sigo siendo así porque para mí esa contradicción no es tal, sino expresión de la misma esencia del ser.
En ese mar de complejidades existenciales fui conociendo y leyendo parte de la obra poética de Miguel Hernández, como tuve mis primeros acercamientos a Pablo Neruda, César Vallejo, Clara Lair, Vladimir Mayakovski, Vicente Huidobro, Charles Baudelaire, García Lorca, Vicente Alexandre, Hugo Margenat, Julia de Burgos, otros tantos poetas nacionales y de otros países. Todos me cautivaron. Unos más que otros.
A ese poeta español de formación autodidacta, Mi-
guel Hernández, que en este 28 de marzo se cumple otro año más de su muerte, escasamente había leído uno o dos poemas.

Nacido en 1910 en Orihuela, cuyos campos, cabras y lecturas de varios de los poetas clásicos de la literatura española como Calderón de la Barca, Luis de Góngora y Garcilaso de la Vega, quedaron como raíces profundas en sus poemas juveniles; la voz literaria más precisa y comprometida con la República Española, condenado a pena de muerte por su compromiso y lealtad a la República, la cual es conmutada, muerto de tuberculosis en la cárcel de Alicante un 28 de marzo de 1942, pero con sus ojos profundamente abiertos, cuyos poemas mantienen la frescura y el calor humano del mismo instante en que fueron escritos y cuyos versos también crean estupor, rencor odio en aquellos que todavía añoran un pasado de fusilamientos, barbarie y terror franco-falangista…
Su imagen y palabra poética llegó a mí por pura casualidad a través de la música y la voz de Joan Manuel Serrat el día en que compré, en la desaparecida Librería la Tertulia, su disco de larga duración en que se musicalizan 10 de sus poemas (c. 1973) y a partir de entonces comencé a leer sobre su vida y obra con sumo interés.
El autor de Perito en Lunas, Elegía (a Ramón Sijé), Vientos del Pueblo, El Hombre Acecha, Cancionero y Romancero de Ausencias, Nanas de la Cebolla; el poeta por excelencia y voz del pueblo durante la República Española me cautivó para siempre.
Corría el año de 1975 y habiendo leído un poco más acerca de su vida, su obra, su compromiso con la República Española y su martirio carcelario, escribí una oda dedicada a Miguel Hernández, que comparto en este momento con motivo del 79 aniversario de su muerte:
Niño pastor de lunas
A Miguel Hernández, Poeta de la República Española y de siempre Caminando va el poeta por esas calles de España, tierra que arrancó a la muerte una postrera mirada como aquel niño pastor de lunas, hortelano de sangre, vida, barro, pueblo, muertes, cabras, palabra viva del hombre que a la España quijotesca, gongorina, juglaresca libertaria y pasionaria consagrada con la ternura del amor en sus pupilas y la más eterna sencillez de su mirada.
Decir Miguel Hernández es decir poesía, ternura, amor, conciencia y compromiso. La fuerza de su voz y su palabra ha tratado de ser invisibilizada, pero su ejemplo y su creación poética que es universal, ha logrado trascender tiempo y espacio.
28 de marzo de 2021.
de hecho más políticos que los políticos, porque con su inacción avalan el status quo, o la sociedad que le circunda, con sus aciertos y sus injusticias.
Ya en 1939, Camila declaró en su ensayo sobre La Mujer y la Cultura, que:
“Las mujeres de excepción de los pasados siglos representaron un progreso en sentido vertical. Fueron precursoras, a veces sembraron ejemplos fructíferos. Pero un movimiento cultural importante es siempre de conjunto y necesita propagarse en sentido horizontal
Laluchacontraelpodereslaluchadelamemoria contraelolvido”
—MilanKundera:“ Lainsoportablelevedaddelser”.
Ladiscusión que se está sosteniendo al interior y exterior de la Academia de Historia, sobre la inclusión de Ramiro Matos, va más allá de las personas que la encarnan. Lo que está en discusión es un viejo paradigma: el del rol del o la intelectual en la sociedad.
En Dominicana es un debate de larga data, recuérdese la Carta de Juan Bosch a los intelectuales de 1954; es perenne entre poetas y nos trasciende. El ejemplo quizá mas célebre en El Caribe, es el de la poeta nacional de Puerto Rico: Julia de Burgos, considerada por Neruda y Bosch como la gran voz emergente de America, cuyo nombre se expandiría, “como el de la sombras cuando el sol declina”.
Frente a su ataúd, en el Ateneo Puertorriqueño, Nilita Vientós, de la Academia de la Lengua, su eterna rival poética y despechada enamorada de Juan Isidro Jímenes Grullón, se atrevió a decir que Julia “hubiera sido una gran poeta si no hubiese incluido en su poesía y ensayos los temas políticos y sociales”, precisamente los que la han convertido en bandera de su nación.
Llama la atención el reclamo de Chez a Mukien: “Cuando yo te presenté en la Academia eras una “académica pura”. Empero, ¿puede existir algo como una “académica pura”, “un poeta puro”, o “un intelectual puro”?
Si “pureza” quiere decir falta de influencia ideológica, ello es imposible. En el caso especifico de Mukien, ella es egresada de la Universidad Católica Madre y Maestra (la cual expulsó el pensamiento liberal de sus aulas desde el inicio de su creación), y es una ferviente admiradora de Monseñor Núñez Collado, quien no necesita presentación y que en paz descanse.
Y es imposible por una simple razón: Porque desde que nacemos nos socializan, con ideas y valores, y nos constituyen (análisis de genero) en ideologías andantes, por eso quienes dicen ser “apolíticos” son
Lo segundo es que no hay escritura “neutral”, como lo están demostrando los actuales estudios sobre la Historia, que siempre ha sido escrita por los vencedores. Por eso, la historia convencional tiene tantas ausencias, y en los Estados Unidos las mujeres están empeñadas en escribir su historia o “Her- story”, en complemento a la “His-tory”, Her,(o de ella), y His (o de él).
Por último, una cosa es perder un ojo en una batalla, y otra fusilar a un grupo de hombres enfermos y desarmados. Claramente lo segundo no constituye una acción heroica, y que el autor de la masacre sea un escritor, o haya publicado libros no le exime del juicio colectivo, como no ha eximido a Celine, uno de los mayores escritores de Francia de su feroz antisemitismo y colaboración con los nazis, razón por la cual no se pudo celebrar su Centenario.
¿Qué lamentamos? Que una hermandad como la de Chez y Mukien se hay podido afectar por alguien que no merece ni que se le mencione.
“Para irradiar luz hay que tenerla, y así sucede con las democracias: sólo proyectan valores si son auténticas. El mundo se parece cada vez menos a nosotros, protestamos, pero hace tiempo que decidimos constituirnos en mausoleo de oro y encerraros en él, y nos ocurre igual que las bibliotecas cuando solo se nutren de si mismas…o las Academias. Nos empobrecemos”.
El Pais. Reseña sobre “El Poder de Nadie”, de Pierre Rosanvallon, profesor del College de France. Teórico sobre “La ideología ascendente de este siglo”. Referencia intelectual de la Francia Contemporánea”.
En el debate sobre Ramiro Matos y su inclusión en la Academia de Historia, uno de los reclamos de Chez Checo a Mukien es que haya dejado de ser una “académica pura” y se haya transformado en una “vedette” que “escribe artículos”, haciendo uso de clichés de internet etc.
Detrás de esa afirmación hay un juicio de valor, el de menosprecio del periodismo por la intelectualidad, al cual consideran vulgar. Y vulgar es si la palabra viene de vulgo, o pueblo, porque quien escribe en los diarios y otros medios de comunicación, lo hace para llegar a la gente, para salirse del círculo cerrado de la llamada intelectualidad.
Habría que recomendarle a quienes sostienen esa posición que lean a la más erudita y completa intelectual de República Dominicana de todos los tiem-

…La mujer necesita desarrollar su carácter en el aspecto colectivo para llevar a término una lucha que está ahora en sus comienzos. Necesita hacer labor de propagación de la cultura que ha podido alcanzar para seguir progresando. Y siempre que la cultura tiene que extenderse, da la impresión de que baja de nivel. Se trata de una ilusión óptica”. Pág. 66, CHU. Feminismo y otros temas.
De esta cita quisiera que recordaran estos postulados:
1 Que todo movimiento cultural importante es siempre de conjunto y necesita propagarse en sentido horizontal.
2 Que la mujer necesita desarrollar su carácter en el aspecto colectivo, para llevar a término una lucha que está ahora en sus comienzos. Y,
3 Que la mujer necesita hacer labor de propagación de la cultura que ha podido alcanzar para seguir progresando.
En 1983 un grupo de jóvenes poetas se organizó en un Círculo, adoptó la enseñanzas de Camila, y denunció a quienes Camila definió como “varonas intelectuales”, las pocas mujeres de excepción aceptadas por los hombres en sus gethoes literarios, que se convierten en sus portavoces; por eso afirmo que la discusión sobre la función de la intelectual en la sociedad es de larga data. Así, un intelectual tan “puro” como Borges apoyó la dictadura de Pinochet, y la lista es larga.
Lo que si nos queda claro es que la sociedad dominicana se ha derechizado, y por esa razón la Academia de la Historia se atrevió a aceptar entre sus filas a una figura tan cuestionada, por Minou y Mukien entre otros y otras, como Ramiro Matos.
El problema es que esta desecralización, o banalización de la Historia, provocada por lo que se ha denominado como “Cuarta Revolución Tecnológica” (las redes sociales, internet, Netflix y otras yerbas) y su fomento de la despolitización, el individualismo, o la falta de empatía, o solidaridad; la promoción de una nebulosa entre el bien y el mal, o lo correcto o incorrecto, justifica la visionaria tristeza de Don Pedro Mir.
La última vez que lo visitamos, su esposa nos dijo que no podríamos verle porque estaba muy enfermo y ya cuando nos disponíamos a salir Don Pedro bajó hacia la sala y nos dijo:
“Me estoy muriendo de la derrota de mi generación, y ustedes también”.
¿Quizás ya es hora de admitirlo?
I¡Alláafueraeselnegrocaminodemiasmas ymisombraacechandotusombraentrefantasmas! —ClaraLair,“Lullabymayor”
Mi casa es el cangrejo del tedio donde se yergue inerte la luz en espera de los insectos de Goethe, cuyas alas, marinas, se estremecen para dejar de ser, en la corriente, el subterráneo intento de violar ese momento tuyo cuando sueñas las manos del amante estremecidas sobre tus muslos cardinales.
Sueño que subes, que sigues subiendo, que en la esbeltez de una esfinge se esconde la presteza de esas manos y su sabiduría de bestia tuya, de animal eterno, de niño que naufraga en tus abrazos para adorarte como se debe, como se debe hacer entre tus labios, donde la muerte no se posa y solo la piedra esgrime su soledad desierta, su soledad de sal, de luz, de aletazos que das si te derramas y, de no hacerlo, se derrama el mar también, como un náufrago amarrado.
Ése soy yo, pero libre, turba, sencillo, para darte músculo y orden, leche estremecida, sensación de poseerte hasta esa orilla donde nos encontramos niños.
Desde esa orilla te regreso hasta el desorden que procuro sin hartarlo —vicio, sueño, pesadilla, hedor, gemido, humedad y sensaciones— porque a él me debo, a la simple excusa de provocar tu cuerpo, ése que es tu medida, tu estuche, humano para el placer y la caricia, clara de plenitud, Clara.
Pequeño homenaje a Clara – Vanessa Droz
Sabía que lo había pasado en limpio. También intuía que, por alguna razón, debía encontrarlo antes de que marzo acabara…
La tarde del jueves 14 de abril de 1994, Edwin Reyes y yo coincidimos, como tantas otras veces, en el Patio de Sam en el Viejo San Juan, ese emblemático lugar que por tantas décadas fuera lugar de tertulia y encuentro para artistas, escritores, músicos y, en fin, amantes de la vieja ciudad. Poco tiempo después dejaría de serlo gracias al desenfoque de un nuevo administrador (español él, “más americano que la bandera americana” él, según sus propias palabras) que prefería de clientela más a los turistas norteamericanos que a los habitués criollos cuyo patrocinio constante le daba estabilidad económica al establecimiento.
No recuerdo cómo surgió el nombre de Clara Lair ni quién había hecho el “cuento” de cómo los últimos años de Clara en la Caleta de las Monjas (cuando “la única aventura que le quedaba era el desorden”, según recordaría Manuel Ramos Otero
en su relato “Clara Gardenia Otero”) se avivaban por el “enamorado” que Clara tenía: aquel guapo policía adscrito a Fortaleza, de nombre Mario, con el que ella soñaba. Cuando Mario se apostaba a hacer guardia en las cercanías de los portones del Palacio de Santa Catalina que dan a la Plazoleta de la Rogativa, a Clara le daba el ánimo de levantarse de su eterna cama para, en la distancia, otearlo ansiosa. La ansiedad es una de las dimensiones del amor “a lo adivino”.
Casi treinta años después —y hace apenas unas semanas—, mientras rescataba y organizaba viejos papeles garabateados, di con este texto que no recordaba. Los papeles, oxidados por el tiempo, con ese tono de cedro añejado, me devolvían, primero, los trazos manuscritos de Reyes y los míos al hacer esta suerte de cadáver exquisito y, también, el texto final pasado en limpio con mi maquinilla eléctrica de entonces. Que el hallazgo coincidiera con la Semana de la Mujer— teniendo en cuenta que Clara nació un 8 de marzo (1895)—, me pareció providencial.
A casi 30 años de la escritura de este texto, a 22 de la muerte de Edwin, a 50 años del fallecimiento de Clara Lair (26 de agosto de 1973) y a 23 de que una breve calle del poniente del Viejo San Juan (antes Recinto Oeste) haya sido bautizada “Calle Clara Lair” (calle por la que, por cierto, ya no caminan guapos policías adscritos a Fortaleza), aquí va, como un homenaje a esa caminante que nunca conocí, un ejercicio que hicieron dos poetas para honrarla a ella, su poesía y un amor imposible.


Martin Scorsese arrebata tu mirada y la lleva en un viaje por el mundo de Hugo Cabret en Hugo (EEUU, Reino Unido y Francia; 2011). En un plano secuencia, Scorsese posa tus ojos sobre París para gozar de la Torre Eiffel al amanecer. De ahí, a través de un trávelin o tracking shot, Scorsese te precipita hacia la estación de tren. Pasas entre maletas y el ir y venir mañanero hasta detenerte ante el alto reloj en el fondo de la estación. Es allí que Hugo (Asa Butterfield), un niño de alrededor de 12 años, observa las tienditas en el vestíbulo. A través del número 4 en el reloj, Hugo localiza el guardián de la estación (Sacha Baron Cohen). A pesar de estar lejos, la cámara de Scorsese usa tus ojos para que Hugo note el detalle del aparato ortopédico que lleva el guardián en su pierna derecha. Junto a Hugo observas fragmentos de la vida de la estación: la vendedora de flores que empuja su carretón; el librero en la entrada de su tienda; un hombre que compra un periódico; y un grupo de música que toca en un café. El niño cierra su mirilla en el reloj. Ahora Scorsese te hala apresuradamente para seguir a Hugo que corre, se tira por una chorrera de muchas curvas y llega a otro reloj. Hugo se acomoda de nuevo frente al 4 a través del cual se fija en un anciano Georges Méliès (Ben Kingsley). Años después de su Viaje a la luna (dir. Georges Méliès, Francia, 1902), Scorsese culmina tu exploración inicial de la estación en la tiendita de juguetes de Méliès, donde el mítico mago del cine juega con un ratoncito de cuerda. El mundo del niño en Hugo está rodeado de maravillosos mecanismos que incluyen el autómata que su pa-
dre dejó, el reloj que su tío alcohólico mantenía, el tren siempre rodeado de nubes de humo, los juguetes de cuerda de Méliès y la cámara de Scorsese. Para el director, el mundo del niño repleto de engranajes comienza en su cámara y en tus ojos e inevitablemente concluye con el maestro Méliès. Hugo es un viaje al pasado para reencontrar el lenguaje visual del maestro.
No obstante, The Quiet Girl (dir. Colm Bairéad, Irlanda, 2022) construye un mundo muy diferente para Cáit (Catherine Clinch). En su hogar, ella es una niña más entre sus hermanas. Su padre está muy ocupado bebiendo y pasando el tiempo libre con su amante. Su madre, que casi permanece ausente a través de la película, está ocupada con las faenas del hogar. Cáit se siente invisible porque en su mundo de disfuncionalidad y negligencia, ella no es una prioridad para nadie. El padre, que solo reconocemos como Da (Michael Patric), decide llevarla donde una prima de su esposa que vive en el campo mientras la madre se prepara para dar a luz de nuevo. Durante ese verano, Cáit descubre un nuevo mundo que se abre ante ella en casa de Eibhlín (Carrie Crowley) y su esposo Seán (Andrew Bennett). Ambos han enfrentado momentos difíciles, pero ellos proveen el amor necesario para que Cáit abra los ojos ante la magia natural de sus alrededores. Diferente al ambiente de Hugo, Cáit transita una naturaleza que la acaricia amorosamente. Ella intercambia su sucio traje y sandalias por pantalones de trabajo y botas de goma. Junto a sus nuevos guías, Cáit va al mar, corre entre los árboles en busca del correo, le da leche a un becerro y escucha el viento entre las hojas. Esa niña tan callada del principio deviene en una joven que ha-

bla a través de sus acciones. Ahora, su silencio no se origina en invisibilidad, sino en que no siempre hay algo que añadir.
Aunque totalmente opuestos, los mundos de Scorsese y Bairéad se definen a través de la mirada encantada de la niñez. En Hugo, el niño persigue su sueño de resucitar el autómata que heredó de su padre en un ambiente que nos recuerda un París lleno de romance y tecnología de las primeras décadas del siglo veinte. Su París es similar al de Playtime (dir. Jacques Tati, Francia e Italia, 1967). Aunque la película de Tati se lleva a cabo durante la década de los sesenta, el director recrea una ciudad que se rige con una coreografía de movimientos mecánicos y que Monsieur Hulot (Jacques Tati) violenta por su presencia. Por otro lado, Bairéad nos invita a gozar de una Irlanda de ensueño donde una niña se encuentra a sí misma en una campiña similar a la de My Neighbor Totoro (dir. Hayao Miyazaki, Japón, 1990). A diferencia de la película de Miyazaki, la magia de The Quiet Girl está en la transformación tan sutilmente lograda de Cáit por su nuevo hogar temporero. Hugo y The Quiet Girl tratan sobre esas familias que escogemos y que nos acompañan durante el camino. Hugo comparte su viaje con Isabelle (Chloë Grace Moretz), la ahijada de Méliès. Con ella, Hugo llega al historiador de cine (Michael Stuhlbarg) que le cuenta que, cuando era pequeño, Méliès le enseñó el lugar donde se crean los sueños en el set de Veinte mil leguas bajo el mar (dir. Georges Méliès, Francia, 1907). Hugo y el historiador le devuelven a un Méliès triste y hastiado ese lenguaje de fantasías mecánicas y maravillas teatrales. Igual que el viaje de Hugo lo lleva a encontrar una familia, el camino de Cáit la dirige hacia un nuevo concepto de hogar y a una nueva forma de expresión. The Quiet Girl es completamente en irlandés, una lengua hablada por tan solo dos millones de personas. Cáit se comunica en un lenguaje casi silente fuera de Irlanda y, al mismo tiempo, encuentra un lenguaje corporal que culmina en un abrazo con la palabra “Papá.”
Si no han visto Hugo, la pueden encontrar en HBO Max y en otros servicios de streaming. A pesar de que The Quiet Girl fue nominada para el Óscar en la categoría de mejor película internacional, solo se ha exhibido en algunos cines en los Estados Unidos. All Quiet on the Western Front ganó el Óscar en la misma categoría y cuenta con un diseño de producción impresionante. Sin embargo, la belleza delicada de The Quiet Girl la hace para mí más merecedora de ese galardón.

Viene de la página 8
en récord lo que entendía perjudicaba a la Procuradora. Es parte de “la función.” No sabemos cuál será el resultado final en cuanto a la confirmación de la Procuradora. Si fuera por los méritos, compromiso con los derechos y la equidad para las mujeres, su independencia de criterio, como requiere la legislación, tendría que ser confirmada. Pero, es muy sombrío lo que ocurre en la Legislatura. Resultan electas personas que no nos representan. Hasta en el caso de muchas de las mujeres que ocupan los escaños, asumen posturas e impulsan legislación que atropella reivindicaciones que ya hemos alcanzado, como han pretendido con los derechos sexuales y reproductivos. Con las excepciones antes mencionadas y a las que sumo a la compañera Mariana Nogales Molinelli junto a pasadas legisladoras como Velda González, Olga Cruz, María Libertad Gómez, no podemos sentirnos orgullosas, sino decepcionadas. En cuanto a los varones, qué podemos decir cuando hay gente como los tres proponentes del disparatado proyecto sobre el aborto que pretendía imponer hasta 25 años de cárcel a la mujer que abortara dentro de las primeras 10 semanas de embarazo y luego del que promueve la castración química de agresores sexuales convictos. Tres actores de “la función” que están en su segundo cuatrienio, pero son desconocidos, excepto en sus casas: José “Memo” González, Yazzer Morales Díaz y Wilson Román López. Si no fuera tan trágico provocaría risa. La Legislatura está picando fuera del hoyo, cuando lo que realmente se necesita es una verdadera fiscalización, no destructiva ni partidista, de lo que hacen las otras ramas de gobierno y también la empresa privada con relación a la legislación y las políticas públicas. También urge tomar medidas contra la corrupción y el inversionismo político. Necesitamos que se legisle para atender las necesidades de la gente y para que haya un desarrollo económico que atienda la pobreza y la dependencia. Las mujeres exigimos un presupuesto nacional con perspectiva de género que tome en cuenta nuestras necesidades. Hemos llegado al límite de tolerancia respecto a las privatizaciones y medidas neoliberales que socaban nuestro futuro como pueblo. Basta de legislar para llamar la atención de los medios de comunicación y para recibir un salario que no justifican con su trabajo. Si Vilmarie Rivera Sierra no es confirmada no veo otra opción que tirar la OPM a pérdida.
Las personas que votamos cada cuatro años, también somos responsables de hacerlo de forma sabia. Desde luego que entendemos y respetamos por qué hay gente que no ejerce esa opción y por ello no pierden el derecho de exigir equidad y justicia.
Por la Redacción de CLARIDAD
Calentando motores para la manifestación de este próximo 1 de mayo la Jornada se Acabaron las Promesas, en una acción sin previo anunció, tomó el lobby del edificio que da acceso a las oficinas de la Junta de Control Fiscal (JCF) en Hato Rey.
En declaraciones a la prensa los portavoces de la Jornada reiteraron y denunciaron el rol de la JCF de mantenernos -al pueblo de Puerto Rico- como rehenes de fondos buitres.
“La Junta Dictatorial de Control Fiscal es responsable del desastre de mediocridad, corrupción y saqueo continuo que vivimos. Ellos continúan sangrando nuestras arcas públicas y nuestros bolsillos con los constantes aumentos en los servicios básicos”.
Jocelyn Velázquez, portavoz, agregó que, “las medidas de austeridad que han impues-
to generan terribles problemas sociales y económicos que empeoran nuestra ya pésima calidad de vida. A más de seis años de estar en funciones lo único que garantizan es premiar a quienes han saqueado el país, y llevarnos a la miseria. Debe quedar claro que tanto el gobierno de Puerto Rico, la Junta Dictatorial de Control Fiscal y el gobierno de EE. UU, son culpables de las pésimas condiciones de salud, seguridad, educación y económicas que vive la gente”.
La Jornada hizo un llamado a que continúen las movilizaciones y tomar las calles de manera masiva este 1 de mayo para que el sistema comprenda que es momento de retroceder. “El pueblo ha demostrado tener la capacidad de crear propuestas concretas para los desafíos que enfrenta el país, los obstáculos son ellos ya que su razón de ser es enriquecer a unos pocos que ostentan el poder”, concluyó.

Con la culminación del reciente juicio en contra del ex alcalde de Guaynabo, Ángel Pérez Otero, se destapó la olla de grillos que hace muchos años se conoce que existe en el país, aunque no al nivel en que se reveló por dos delincuentes confesos cuyos testimonios fueron parte del proceso. Estos individuos, uno de ellos exalcalde y otro abogado y empresario, aprovechando sus respectivas ocupaciones, disfrutaron del producto de sus fechorías, a costa del tesoro municipal. Ambos individuos, militantes del PNP, escalaron posiciones dentro de ese partido para lograr acceso a figuras de poder dentro de esa colectividad, quienes les abrieron paso hasta alcanzar sus aspiraciones de enriquecerse, desmedidamente, con dinero público. El abogado, Oscar Santamaría, quien inició su carrera como asesor legislativo de diversos legisladores del PNP fue, astutamente, acomodándose en los círculos controlados por ese partido, desde donde comenzó a extender sus tentáculos a los municipios. Hoy se conoce, que Santamaria participaba de reuniones del comité directivo del PNP y de la Federación de alcaldes que agrupa a los alcaldes de ese partido. Santamaría, bajo diversos frentes corporativos y valiéndose del sistema de financiamiento de campañas políticas que impera en el país, ideó un esquema mediante el cual comenzó a sobornar a alcaldes inescrupulosos dispuestos a malversar dinero público a cambio de lucro personal.
Uno de estos alcaldes inescrupulosos resultó ser Félix “El Cano” Delgado, exalcalde del municipio de Cataño y hoy convicto por actos de corrupción, quien se inició en la faena política de la mano de la representante del PNP, Maria Milagros Charbonier, acusada actualmente por corrupción en la esfera federal por, entre otras cosas, obtener “kickbacks” de sus empleados. Cegado por el poder, la fama y el dinero, “El Cano”, se convirtió en presa fácil de Santamaría, quien obtuvo contratos del municipio de Cataño para tres de sus empresas: Waste Collection, VIP Healthcare e Island Builders. La ostentación que hacía “El Cano” Delgado de la ropa, joyas y autos que adquiría con dinero sucio llamó la atención de las autoridades federales quienes, tras investigarlo, lo usaron de señuelo para revelar el esquema que llevó, posteriormente, al arresto de contratistas, alcaldes y otros funcionarios municipales del PNP y del PPD.
Como parte del acuerdo de cooperación con las autoridades federales, “El Cano” Delgado grabó a Santamaria mientras le entregaba dinero al exalcalde. Esas imágenes le fueron divulgadas al contratista, quien viéndose arrinconado por sus actos criminales, decidió cooperar también para beneficiarse en la sentencia que en su día se le impondría. La prensa revela que dieciséis días después de decidir que cooperaría, hizo su primera grabación a Pérez Otero. La cooperación de Santamaría destapó la magnitud del esquema mafioso que había puesto en marcha y

con el que se involucraron tanto alcaldes del PNP como del PPD. Sus primeros contratos los obtuvo con los municipios de Aguas Buenas, bajo Luis Arroyo Chiqués del PPD y de Cidra, bajo Javier Carrasquillo del PNP, lo que le permitió comenzar a amasar una considerable fortuna. En Cidra comenzó como asesor legal del municipio y, mientras se desempeñaba en esa capacidad, creó una compañía de recogido de desperdicios sólidos, a la cual Carrasquillo le otorgó un contrato, sin que fuera sometido a subasta y sin la aprobación de la legislatura municipal. Santamaría logró obtener contratos con 16 municipios. Luego de abandonar la alcaldía, Arroyo Chiqués fue procesado por los federales por estar recibiendo sobornos de parte de Santamaria ascendentes a $5,000.00 mensuales. Tras perder las elecciones del año 2020 a la alcaldía de Cidra, el gobernador Pierluisi cobijó a Carrasquillo, nombrándolo asesor de asuntos municipales en la Fortaleza, puesto al que renunció el pasado año una vez se anunció el nombramiento de un FEI para investigarlo.
Poco después de que cayera Santamaría, se dieron los arrestos de otros alcaldes y funcionarios municipales que participaron
de los esquemas de soborno. Entre ellos, fueron arrestados el alcalde de Guayama, Eduardo Cintrón, el alcalde de Trujillo Alto, José Luis Cruz, ambos del PPD, el alcalde de Humacao, Reynaldo Vargas y el alcalde de Aguas Buenas, Javier García Pérez, ambos del PNP, lo que puso de manifiesto un bipartidismo carcomido por la corrupción. Funcionarios públicos de ambos partidos cedieron ante la tentación de obtener dinero mal habido, defraudando la confianza de los constituyentes de sus respectivos municipios, a quienes despojaron de los recursos económicos necesarios para garantizarles los servicios básicos a los que tienen derecho. De todos estos funcionarios, solo Pérez Otero decidió enfrentar juicio, habiendo sido declarado culpable por un jurado, por los tres cargos que le fueron imputados. Como si ello fuera poco, Santamaria confesó haber realizado donativos ilegales a las campañas políticas de varios funcionarios públicos entre ellos, el alcalde de San Juan, Miguel Romero y el senador por Bayamón, Carmelo Ríos. Este último, se dice, está siendo investigado por las autoridades federales, mientras que el alcalde de San Juan fue señalado, junto a los legisladores, Georgie Navarro, Juan Oscar Morales y Víctor Parés, todos del PNP, por recibir asfalto gratis en sus campañas de la compañía J. R. Asphalt, cuyos directivos fueron procesados y convictos por participar, igualmente, de esquemas de sobornos. Tanto el Departamento de Justicia como la Oficina del Panel del Fiscal Especial Independiente, rechazaron acusarlos por estos cargos.
En fin, la olla de grillos que se ha destapado con los testimonios de “El Cano” Delgado y Oscar Santamaría, ha develado la podredumbre que ha generado el inversionismo político y que enloda tanto al PPD como al PNP. Este es el mismo bipartidismo responsable del colosal endeudamiento del país, que ha traído un creciente empobrecimiento de nuestra gente y el deterioro acelerado de nuestra calidad de vida. Esta tétrica situación ha provocado que gran parte de nuestro pueblo haya perdido la fe en los políticos, en las instituciones, en que un cambio es posible. A quienes combatimos el bipartidismo vetusto, inservible y corrupto, nos toca reavivar la esperanza en estos compatriotas, de que nuestro país cuenta con mucha gente decente, comprometida y luchadora, dispuesta a trabajar por sanear la administración pública y construir el país que queremos y que nos merecemos.
El diplomático Venezolano, Alex Saab, sigue preso en gulags de los Estados Unidos de América. Su salud ha empeorado. Su vida está en peligro. Exhortamos a que se unan a la campaña por su inmediata excarcelación.
Porque somos Puertorriqueños(as) que amamos la justicia y la libertad, hemos decidido exigirle al gobierno de los Estados Unidos de América (EEUU) que excarcele de inmediato a Alex Saab.
Hace dos años y ocho meses que el gobierno estadounidense ha secuestrado a Alex Saab en un acto craso de violación de los derechos humanos y leyes internacionales. El secuestro y encarcelación de Saab son actos de lesa humanidad. También son actos de lesa humanidad negarle acceso y visitas a su familia, esposa e hijos de 12 años y a su bebé recién nacida.
Siendo los EEUU los secuestradores y violadores de estos derechos fundamentales, tenemos toda la obligación de protestar y seguir luchando por su excarcelación y atención médica.
La salud de Alex Saab corre peligro. Su cáncer se ha adelantado y está en necesidad urgente de atención médica. Alex y su familia siguen siendo víctimas de un gobierno que practica la lesa humanidad, o sea, un crimen “legal” como lo ha catalogado Amnistía Internacional.
Le exhortamos a todas las personas que aman la justicia y la libertad a que se unan a esta campaña. Les pedimos que a su vez que apoyen y luchen por la excarcelación inmediata de Alex Saab. Hagamos todo lo posible para que Alex Saab pueda ser excarcelado lo antes posible y él pueda recu-

Internews Service
El presidente de la Universidad de Puerto Rico (UPR), Luis A. Ferrao, confirmó que lograron un acuerdo con el Sindicato de Trabajadores que pone fin a la huelga que comenzó el miércoles, 15 de febrero.
“Siempre hemos reconocido la urgencia de hacerle justicia salarial a los empleados de la Universidad de Puerto Rico. Desde que asumí la presidencia he tenido como prioridad atender esta necesidad, nos comprometemos a que los empleados formen parte y se beneficien del aumento de salario mediante la petición presupuestaria a la Oficina de Gerencia y Presupuesto, la cual tendría que ser aprobada por la Legislatura y por la Junta de Supervisión Fiscal”, expresó el presidente del primer centro do-
cente de la isla.
Ferrao añadió que también acordaron una bonificación no recurrente de $2,750 para el Sindicato de Trabajadores. Este acuerdo pone fin a la huelga y por ende se retira el recurso sometido por la UPR, para el cual había vista señalada para mañana martes en el Tribunal de Instancia en San Juan.
Agradezco el respaldo del presidente de la Junta de Gobierno, Ricardo Dalmau, y demás miembros de la Junta dijo, Ferrao.
perar su salud y a su vez pueda disfrutar de la vida junto a su esposa e hijos.
Oscar López Rivera
Luis Rosa Pérez
Adolfo Matos Antorgiorgi
Reproducido de: lavozdelpaseoboricua.org
QUE DESCANSE EN PAZ, DON JULIO MANUEL MARCANO PÉREZ
Desde CLARIDAD, le enviamos un abrazo fuerte y solidario a nuestro querido compañero, abogado y miembro de nuestra Junta Directiva Julito Marcano, ante el fallecimiento de su señor padre, Julio Manuel Marcano Perez.
Que nuestros deseos de paz y fortaleza sean compartidos junto a toda su familia, la de sangre y la extendida.
Junta Directiva Colectivo CLARIDAD Por Aarón Gamaliel Ramos Especial para CLARIDAD
Por Aarón Gamaliel Ramos Especial para CLARIDAD
Este es el tercero de tres artículos sobre Haití dirigidos a conocer las raíces históricas de su actual crisis.
Finalizada la Segunda Guerra Mundial e iniciada la Guerra Fría, Estados Unidos fue delineando una política hacia América Latina dirigida a apoyar a viejos dictadores y a promover nuevos déspotas. En algunos casos se alentaba la continuidad de las presidencias autoritarias instaladas durante las primeras décadas del siglo veinte. En otros se fomentaba el surgimiento nuevas dictaduras, dirigidas por familias que usurparían el poder político con el doble objetivo de reprimir a los movimientos populares y facilitar el flujo del capital estadounidense hacia América Latina y el Caribe.
Las dictaduras configuraban una modalidad de administración pública que, como sugiere Jean Casimir, reproducían los rasgos del antiguo estado colonial, orientado hacia los intereses europeos, pero con manejadores internos. Michel Rolph Trouillot lo catalogaba como un Estado nacional colocado de espaldas de la nación a la que se presume gobernar.
He aquí algunos casos históricos. La dictadura de la familia de Anastasio Somoza García, iniciada durante los años treinta del siglo veinte, fue continuada por sus dos hijos —Luis Somoza Debayle y Anastasio Somoza Debayle — hasta 1978, cuando el Frente Sandinista tomó el control del Palacio Nacional en ruta hacia la victoria de la revolución sandinista. De ese período fueron también las dictaduras de Fulgencio Batista, entre 1952 y 1959, la de Gustavo Rojas Pinilla, entre 1953 y 1957, y la de Carlos Castillo Armas, entre 1954 y 1957. Todos ellos tuvieron en común el enriquecimiento de una familia, tanto la de sangre como la política, popularizada en la aseveración de las tres “p” que solía enunciar la familia Somoza, «Plata para los amigos, palo para los indiferentes, plomo para los enemigos.
A ese hábitat de dictadores se unió François Duvalier, como producto de procesos similares: el interés de una familia
en controlar las riendas del gobierno, la celebración de elecciones maniatadas, y la organización de ejércitos que estaban menos interesados en proteger la nación que en flagelar a sus ciudadanos. Todas ellas tuvieron también en común su colocación de espaldas a los habitantes de la nación cuyos intereses decían representar.
Gérard Pierre Charles, con la agudeza para interpretar la sociedad haitiana que le caracterizó, solía repasar lo que era particular del mundo dictatorial haitiano, destacando el hecho que, mientras los dictadores de América Latina adornaron su autoritarismo con un despliegue de edificaciones que pretendían destacar su grandeza, la dictadura duvalierista ni siquiera eso hizo, dejando a su paso apenas un país en ruinas.
El examen del Estado duvalierista en sus dos etapas -- la de François Duvalier (1957-71), y la de su hijo Jean Claude Duvalier (1971-1986) -- es importante para comprender la coyuntura actual que vive Haití. Durante este período de casi tres décadas, se gestó el modelo de un Estado articulado para el pillaje, que se sostuvo mediante la represión, el exilio forzoso de sus ciudadanos, el asesinato de sus opositores, y el apoyo de países que interesaban sus mercancías agrícolas.
Cultivó el absolutismo político, que impulsaba el control perpetuo de las riendas del Estado, lo cual sintetizó en el título de président à vie, mote autoimpuesto que
destacaba la perpetuidad de su mandato. Además, reorganizó el ejército haitiano con oficiales leales a él, y cultivó un nacionalismo negro que pretendía mantener a raya al poderoso sector mulato de la sociedad haitiana. Sobre todo, fue un Estado temeroso de la crítica proveniente de los sectores de la sociedad que aspiraban a la organización de un Estado moderno y democrático como fundamento del desarrollo del país.
Para controlar a ese sector, creó una guardia de Ton-Ton Macoutes, que actuaba como policía privada del dictador, cultivando el terror en la población, asesinando a millares de ciudadanos, y promoviendo el exilio forzoso de innumerables profesionales, los cuales se instalaron en países de América y Europa, impedidos de contribuir a la vida de un país necesitado de sus conocimientos. Es decir, en Haití se erigió un Estado que, en lugar de cumplir con sus funciones básicas (la de organizar la sociedad, proveer servicios básicos a la población y velar por el orden y la justicia) se erigió una empresa para el pillaje en beneficio de la familia que controlaba sus riendas y de los sectores extranjeros interesados en los recursos del país.
Durante el breve período de Jean Claude la comunidad internacional remitió a Haití cerca de mil millones de dólares que, lejos de utilizarse para el propósito expresado del desarrollo del país, fueron a parar a los bolsillos de la familia Duvalier y de las élites haitianas. La organización Transparencia Internacional estimó que, a su salida
de Haití en 1986, el hijo del dictador, Jean Claude Duvalier, había sustraído cerca de 800 millones de dólares del tesoro público.
En el interés de contar con un gobierno domesticado en el marco de la Guerra Fría, Estados Unidos promovió el derrumbe de la gobernabilidad democrática que predicaba al mundo. Priorizando sus intereses económicos y geopolíticos por encima del bienestar de Haití, apoyó la subordinación de la justicia a los caprichos del dictador, el abandono de la infraestructura del país, el empobrecimiento de las mayorías campesinas y la salida masiva de profesionales.
Si bien Estados Unidos manifestó oficialmente su desprecio hacia Duvalier (sobre todo por la muerte de un ciudadano estadounidense a manos de un policía del gobierno duvalierista en 1957), acabó articulando un plan de reconciliación con la violenta dictadura de la familia Duvalier a la vez que ofrecía lecciones de democracia al mundo. El plan comprendía un fondo de asistencia económica para Haití y un acuerdo de cooperación militar entre ambos países que incluía programas de adiestramiento militar y visitas periódicas de la armada estadounidense a puertos haitianos. Todo ello le vino como anillo al dedo, luego de que arrancara la Revolución Cubana en 1959.
El fin de la dictadura puso de relieve las diferentes fuerzas políticas interesadas en controlar el Estado haitiano. Muchas de ellas tuvieron como objetivo su desmantelamiento; otras proclamaron su interés en proveer continuidad al duvalierismo.

El conjunto de fuerzas políticas democráticas que florecieron en esa coyuntura se vio fortalecido por la acelerada expansión urbana que fue impulsada por la crisis en las regiones rurales del país. Como resultado de ese proceso surgieron innumerables entidades urbanas que parecían anunciar una ruta para el desarrollo de Haití, entre ellas: cooperativas de campesinos, organizaciones obreras, asociaciones profesionales, entidades educativas, y los sectores más conscientes del ámbito religioso. El Haití de los años noventa del siglo veinte exhibía un conjunto de organizaciones de diversas orientaciones políticas con diversas visiones para iniciar el desarrollo del país, modernizar su infraestructura, y disminuir la amplia brecha entre las clases sociales.
El enorme obstáculo que encontraron en ese camino fue la oposición del ejército haitiano, temeroso de perder el control del Estado depredador haitiano, de una
burguesía acostumbrada a beneficiarse de una masa de trabajadores empobrecidos, y de un imperio estadounidense, más seducido con el objetivo de proveer continuidad a sus intereses económicos y geopolíticos, que en el desarrollo de la primera república negra del planeta. A ello se sumaba el hecho de que, luego del derrumbe de la dictadura Duvalier, varios sectores de la clase política interesados en controlar las riendas del Estado reprodujeron las peores tácticas del duvalierismo, tales como la organización de cuadrillas armadas para destruir a sus opositores, creando asimismo condiciones de inseguridad en las calles de las principales ciudades del país con el objetivo de imposibilitar las movilizaciones dirigidas a iniciar el camino hacia la democracia y el igualitarismo en una sociedad de abismales desigualdades.
A pesar de toda la represión, numerosas organizaciones políticas se congregaron en el hotel Montana, en Pétion-Ville, en agosto de 2021, para considerar modos de poner fin a la crisis que vive el país. En la Declaración de Principios del acuerdo al que arribaron, denominado Acuerdo de Montana, afirmaban su visión de que “no es posible renunciar a los derechos a la vida, la libertad, la igualdad de acceso a las oportunidades, la copropiedad de la riqueza nacional, los frutos de la unidad en nuestras luchas armadas y nuestras victorias políticas históricas.” Reclamaban también que “la protección de estos derechos y la transparencia en la gobernabilidad democrática debía ser establecida sobre la base de la participación ciudadana inclusiva en la construcción y funcionamiento de las instituciones estatales”.
El acuerdo, que fue firmado porcientos de organizaciones y gremios, proponía también la designación temporera de personas para ocupar los puestos de jefe de Estado y primer ministro como parte de un gobierno de transición de dos años, el cual lidiaría con la aguda crisis del país y empoderaría
a las instituciones estatales, como paso previo a la programación de elecciones.
Ese plan fue repudiado por la clase política haitiana y la llamada “comunidad internacional”, la cual prefiere las intervenciones militares para solucionar los problemas que enfrenta Haití, como lo fueron la Misión de Estabilización de las Naciones Unidas en Haití (MINUSTAH, 2004), y la Misión de Apoyo a la Justicia en Haití (MINUJUSTH, 2018). Por sus amargos frutos, es evidente que, lejos de beneficiar a Haití, han sido un enorme peñón, obstaculizando el camino hacia el desarrollo del país.
A pesar de la magnitud de la violencia interna en Haití, la oposición a la vía militar se ha incrementado, tanto en el país como en el exterior. El pasado año, cuando el primer ministro Ariel Henry solicitó la intervención de fuerzas armadas estadounidenses para lidiar con la violencia en las calles de Puerto Príncipe, varias organizaciones estadounidenses manifestaron su oposición a esa propuesta, incluyendo la organización religiosa Global Ministries, la cual invitó al presidente de los Estados Unidos a “escuchar a la sociedad civil haitiana, y a respetar los derechos fundamentales del pueblo de Haití con el fin de adelantar soluciones haitianas a los problemas de ese país”.
Además, las intervenciones militares en Haití, protagonizadas precisamente por ejércitos de países que han despreciado a ese pueblo a lo largo de dos siglos, solo han servido para proteger los intereses de la oligarquía haitiana y el de las organizaciones que aspiran a controlar el Estado de Haití, influenciadas por el duvalierismo, las cuales se nutren de cuadrillas armadas para ganar terreno en su aspiración por el control del Estado.
Son claras las dos grandes posturas frente al desafío que enfrenta nuestra hermana nación. Entre el terror y la democratización, nos toca manifestarnos en contra de las intervenciones militares, y a favor de la construcción de un Estado haitiano con su mirada puesta en el bienestar de la nación que inició el fin de la esclavización humana en nuestra América.
La Organización del Tratado del Atlántico Norte (OTAN) fue establecida el 4 de abril de 1949. Se trata de una organización militar internacional de países con el objetivo de garantizar la libertad y la seguridad de sus Estados miembros, a través de una acción mancomunada de medios políticos, diplomáticos y militares. La OTAN constituye un sistema de defensa colectiva, en el cual los Estados integrantes acordaron defender a cualquiera de sus miembros que sea atacado por una potencia externa.

En el Artículo V de su carta constitutiva dice que: “Las Partes acuerdan que un ataque armado contra una o más de ellas, que tenga lugar en Europa o en América del Norte, será considerado como un ataque dirigido contra todas ellas, y en consecuencia, acuerdan que si tal ataque se produce, cada una de ellas, en ejercicio del derecho de legítima defensa individual o colectiva reconocido por el artículo 51 de la Carta de las Naciones Unidas, ayudará a la Parte o Partes atacadas, adoptando seguidamente, de forma individual y de acuerdo con las otras Partes, las medidas que juzgue necesarias, incluso el empleo de la fuerza armada, para restablecer la seguridad en la zona del Atlántico Norte.”
Los países que actualmente son miembros de la OTAN son: Albania, Alemania, Bélgica, Bulgaria, Canadá, Croacia, Dinamarca, Eslovaquia, Eslovenia, España, Estados Unidos, Estonia, Francia, Grecia, Hungría, Islandia, Italia, Letonia, Lituania, Luxemburgo, Macedonia del Norte, Montenegro, Noruega, Países Bajos, Polonia, Portugal, Reino Unido, República Checa, Rumanía y Turquía, Suecia* y Finlandia.* (* Ingresaron en el 2022).
Desde su creación en 1949, la OTAN ha intervenido en la Guerra del Golfo, Caída de la URSS, Libia I, Bosnia y Herzegovina, el 11 de septiembre de 2001, Estados Unidos, luego de los ataques terroristas de al Qaeda, Macedonia del Norte, Invasión de Iraq- 2003, Libia II, Actividades contra la piratería en África, Kosovo, Macedonia del Norte, Iraq, Vigilancia aérea Europa y Atlántico, y Asistencia a la Unión Africana.

En la actual condiciones de la guerra desatada por Rusia contra Ucrania se ha creado una situación de solidaridad occidental
a favor de Ucrania. Los países occidentales y la poderosa OTAN han tomado fuertes represalias económicas y políticas contra Rusia con el fin de ahogar su economía.
La solidaridad de la OTAN con esta guerra dirigida por el imperio estadounidense podría llevar al mundo a una Tercera Guerra Mundial. El pacto solidario de defensa se ha convertido en un grupo de agresión por lo que los países tienen que mirar con mucho cuidado su adhesión. Esa organización es terrorista.
Hace pocas horas Putin acusó a la OTAN de “crear un Nuevo Eje” como lo hizo la Alemania nazi antes de que comenzara la devastadora Segunda Guerra Mundial. También aseguró que Ucrania no podría su-
perar a Rusia a pesar de toda la ayuda que recibe de las potencias occidentales como Estados Unidos y el Reino Unido.
La aseveración de Putin es consecuente con su posición de que el actual gobierno de Ucrania protege y ha incorporado múltiples grupos neonazis en su milicia y que en todo su territorio hay grupos nazis que gozan del respaldo del gobierno ucraniano. La milicia fue fundada por Andriy Biletsky, una figura política ultranacionalista que anteriormente lideró grupos como la Asamblea Nacional Social (SNA), abiertamente neonazi, que predicaba una ideología de pureza racial para Ucrania. No sabemos porque occidente y la OTAN, respaldan un gobierno abiertamente pro-nazi.
La Habana, Cuba-El pueblo cubano volvió a las urnas el pasado 26 de marzo para ratificar en elecciones nacionales a los 470 nominados a diputados a la Asamblea Nacional, que conformarán la nueva legislatura del máximo órgano legislativo del país y cuya primera responsabilidad será la de elegir al Presidente y Vicepresidente de la República.
Más de seis millones de ciudadanos, de unos 8,1 millones que estaban habilitados en el padrón electoral, dieron su voto, alcanzando una participación electoral del 75.92%, según datos del Consejo Electoral Nacional, una cifra alta si se compara con igual tipo de comicios en otros países de la región donde el voto, al igual que en Cuba, no es obligatorio.
Esta votación es la continuación de un proceso electoral que arrancó en noviembre del año pasado con las elecciones de los delegados de circunscripción, que conforman las Asambleas Municipales, o sea, los órganos locales de gobierno en cada provincia.
Estas son además las primeras elecciones legislativas que se celebran en el país desde la aprobación de la nueva Constitución en 2019. Los nuevos diputados ocuparán su cargo por un período de cinco años y estarán a cargo, entre otras tareas, de la discusión y aprobación de nuevas leyes, la aprobación del presupuesto del Estado y el monitoreo del buen cumplimiento de las diversas áreas del Gobierno.
Si bien la jornada electoral transcurrió con normalidad –como suele ser habitual en el país– la celebración de estas nuevas elecciones en Cuba no ha estado exenta de polémica. Desde hace semanas, sectores de cubanos en el exterior llamaban a boicotear los comicios en un intento por provocar una alta abstención del electorado. En su cuenta en twitter, la Embajada de Estados Unidos en La Habana, así como funcionarios estadounidenses también criticaron el proceso, tildándolo de “antidemocrático”, acusaciones que provocaron una dura respuesta del gobierno cubano.
En declaraciones a la prensa, el presidente Miguel Díaz-Canel, quien ejerció su voto en la ciudad de Santa Clara –su ciudad
natal y donde fue nominado a candidato–, rechazó las expresiones injerencistas de la Embajada estadounidense y criticó el que, según él, “los Estados Unidos y su gobierno siempre tienen una narrativa hostil hacia Cuba, no podemos esperar otra cosa”.

A una pregunta concreta de Claridad sobre los comentarios de funcionarios estadounidenses, Díaz-Canel sostuvo que “nosotros no vivimos pendiente de esa narrativa hostil, imaginaria, calumniosa, virtual, provocadora y mentirosa.”
“Si lo fuéramos a decir en buen cubano: nos resbalan las opiniones irrespetuosas del gobierno de los Estados Unidos.”, sentenció el jefe de Estado cubano.
Desde el exterior, los medios corporativos han centrado sus cañones de luz sobre la presunta baja participación en estas elecciones legislativas. Para Cuba, acostumbrada, por décadas, a cifras que superaban el 90%, no es menos cierto que el número de votantes en el más reciente proceso pudiera ser visto como una cifra relativamente baja. Sin embargo, la mayor de las Antillas sigue teniendo una de las participaciones más altas para unos comicios parlamentarios de entre todos los países de la región cuyo voto no es obligatorio.
Empero, si se quiere explicar el fenómeno de la baja participación, razones disímiles hay. Cuba atraviesa hoy su peor contexto económico desde el llamado “Período Especial”. La isla ha debido enfrentar nuevas y más violentas sanciones sobrepuestas por el gobierno de Estados Unidos al ya conocido bloqueo económico, financiero y comercial, que se mantiene vigente desde hace más de seis décadas. Ahunado a esto, están los consabidos problemas de desabastecimiento de ciertos productos y un aumento considerable
del costo de vida en el país en los últimos dos años. Factores que han generado cierto malestar en la población.
Por otro lado, de las anteriores circunstancias ha derivado el mayor éxodo migratorio que ha sufrido el país caribeño en los últimos 20 años, con una importante pérdida de jóvenes y de fuerza laboral, que emigran en busca de mejores condiciones económicas.
Precisamente, sobre esta problemática, el mandatario cubano expresó que “sí, nos preocupa [porque] se va fuerza de trabajo calificada, se nos van jóvenes”, pero dijo tener esperanza en que “al final, una parte importante [de quienes emigran] siempre regresará porque esta es su Patria”.
Ante un escenario como este, lo sorprendente realmente es que la asbtención en las elecciones no hubiese sido mayor, lo que demostraría que, en medio de las adversidades, el pueblo cubano sigue apostando por la unidad de su proceso revolucionario. Desde el gobierno de La Habana han asegurado que “Cuba ganó” con estos comicios al lograr movilizar a un alto porciento de la población a votar, a pesar de las situaciones adversas que aquejan al país.
La nueva legislatura deberá quedar oficialmente conformada el próximo 19 de abril en su primera sesión, donde votará por los nominados a Presidente y Vicepresidente. Para esa votación, no se prevé sorpresa y se espera que el actual mandatario sea ratificado en su cargo. Una vez ocupado estos escaños, el Presidente propondrá las figuras de Gobernadores de las provincias, que irán entonces a votación en sus territorios, dando por completado el marco electoral para este período gubernamental que arranca en 2023.
Plan Drácula: Negociaciones secretas entre Muñoz y La Marina

Evelyn Vélez Rodríguez $15.
Clemente

Ángel R. Cabán González $25.
La generación que tomó las calles Manuel de J. González $20.

La insurrección del Cacique Humacao

Fernando Acosta $10.
Tambor

Francis Carrasquillo Sáez $20.
Claritienda
Urb. Santa Rita
Calle Borinqueña #57
Río Piedras
787-777-0534
Hacemos envíos